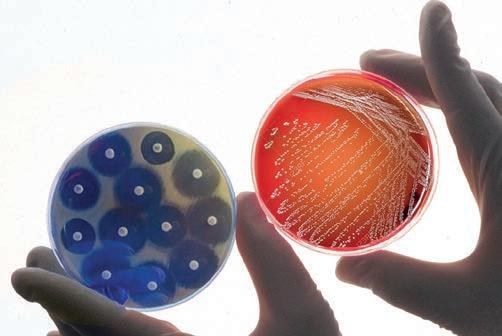

Biosicurezza nell’allevamento avicolo: uno strumento efficace per combattere le malattie infettive
Gestione della lettiera del pollo
Aggiornamento sulla malattia di Marek: situazione attuale e prospettive future
2024
Zootecnica International –gennaio 2024 –POSTE ITALIANE S.p.A. –Spedizione in Abbonamento Postale 70%, DCB Firenze 1


CODAF Poultry Equipment Manufacturers • Via Cavour, 74/76 • 25010 Isorella (Brescia), ITALY Tel. +39 030 9958156 • Fax: +39 030 9952810 • info@codaf.net • www.codaf.net
Nuove tramoggette della serie «Gió» Appositamente realizzate per grandi allevamenti, grazie alla facile regolazione della quantità di mangime e all'assenza della griglia (che impedisce ai pulcini di rimanere intrappolati), le tramoggette Gió presentano numerosi vantaggi: semplici da usare e veloci da pulire, portano ad una notevole riduzione dei costi di lavoro.
EDITORIALE

Lo spreco alimentare rappresenta un argomento sempre attuale. Negli anni ’60 le famiglie gettavano il 40% del cibo acquistato (quando il frigorifero era ormai presente in quasi tutte le case) e anche nei bilanci della Grande Distribuzione lo spreco assumeva una voce significativa.
Dal 2000 è diminuito sempre più, rispecchiando una crescente crisi economica che ha comportato anche una maggiore consapevolezza nella spesa alimentare. L’avicoltura, in questo contesto, ha dimostrato di essere il comparto alimentare più attento alle mutate esigenze del consumatore, ai nuovi stili di vita, alle crescenti richieste in termini di salubrità e sostenibilità. I prodotti avicoli sono i più richiesti a livello mondiale, non solo perché non esistono barriere religiose che ne limitino l’uso, ma anche perché, come è risaputo, essi sono i più economici per il consumatore.
È diventata notevole l’attenzione al perseguimento di minore spreco anche da parte della ristorazione, che utilizza attrezzature tecnologicamente sempre più mirate, investendo anche nella conoscenza del prodotto da parte di chi deve prepararlo e cucinarlo. Ho il privilegio di avere mio figlio Jacopo che è cuoco in un ristorante stellato e, grazie a lui, mi tengo informato sulle novità del settore. Da qualche tempo le famose stelle Michelin si sono tinte di verde per premiare chi è virtuoso nei confronti dell’ambiente.
Dobbiamo essere orgogliosi di operare in un settore molto importante per l’alimentazione umana. Dovremmo anche renderci ambasciatori di notizie che aiutino a conoscere meglio e ad apprezzare il sacrificio di tanti addetti ai lavori.
La chiave del tuo profitto!
Il tempo passa, la qualità persiste!
75 anni di progresso

Da 75 anni, l’industria internazionale delle uova è in costante progresso e anche noi lo siamo! H&N celebra la propria storia in un settore da sempre in continua evoluzione. Il ruolo importante che ci siamo ritagliati ci riempie di orgoglio: siamo all'avanguardia grazie alla nostra costante innovazione e crescita. Basti pensare alle nostre Super Nick e Brown Nick che rappresentano un concetto perfetto di uova: colore uniforme, guscio resistente e valore nutrizionale eccezionale. Grazie all’impegno e alla professionalità del nostro team, il cliente è sempre al centro dei nostri progetti. Siamo pronti a crescere ancora. Cresci insieme a noi! www.hn-int.com
H&N ITALIA SRL Via Ballarini, 1 – 27100 Pavia – Email: info@hnitalia.it – Tel.: +39 348 0154327



SOMMARIO ATTUALITÀ 4 REPORTAGE Biosicurezza nell’allevamento avicolo: uno strumento efficace per combattere le malattie infettive ................................10 DOSSIER L’apporto di nucleotidi aiuta a prevenire enterite necrotica e coccidiosi 16 FOCUS Gestione della lettiera del pollo ....................................................................... 20 MARKETING Dinamiche e modelli del commercio di carne avicola tra il 2012 e il 2022 negli Stati Uniti 26 NUTRIZIONISTICA Indagine sull’impatto di un composto di tre ceppi di probiotici sulle prestazioni dell’asse intestino-encefalo .................................................... 32 VETERINARIA Aggiornamento sulla malattia di Marek: situazione attuale e prospettive future 36 MARKET GUIDE 44 GUIDA INTERNET 48 36 20 10
Benessere animale in avicoltura: successo del corso di formazione promosso da Unaitalia e realizzato dall’IZSAM
Si è concluso a Teramo, presso la sede dell’Istituto Zooprofilattico Sperimentale Abruzzo e Molise ‘G. Caporale’ (IZSAM), il corso di formazione “Il benessere animale negli allevamenti avicoli. Principi, aspetti normativi, applicazioni pratiche”, dedicato a veterinari, responsabili qualità e benessere animale e tecnici aziendali.

Oltre 40 i partecipanti al progetto ideato da Unaitalia, in collaborazione con i Reparti Formazione e Progettazione e Benessere Animale dell’IZSAM, e con il supporto incondizionato di MSD Animal Health Italia. Coinvolti nella didattica anche il Centro di Referenza Nazionale per il Benessere Animale (CReNBA) dell’Istituto Zooprofilattico Sperimentale della Lombardia e dell’Emilia-Romagna (IZSLER) e l’Università degli Studi di Milano.
Il percorso formativo, strutturato in diversi moduli, ha visto la realizzazione dell’attività in presenza che è stata articolata in tre giornate, nelle quali docenti ed esperti in materia di benessere animale hanno fornito ai partecipanti una preparazione teorica e pratica. Attraverso metodologie didattiche che hanno visto l’alternarsi di momenti formativi a distanza e in presenza, la formazione esperienziale, il coinvolgimento attivo dei discenti e le esercitazioni pratiche in allevamento, i partecipanti
hanno acquisito un bagaglio teorico e operativo per poter trasferire correttamente ed efficacemente le competenze acquisite a tutto il personale interessato all’interno dell’azienda, secondo la logica della formazione a cascata, così da raggiungere un numero ancora più ampio di soggetti. Seguirà, nei primi mesi del 2024, una fase di followup presso i destinatari finali per verificare l’efficacia del progetto formativo.
L’iniziativa formativa ha ottenuto il riconoscimento di 19 crediti ECM per la figura del Veterinario e l’abilitazione ai sensi del DM 6 settembre 2023 alla qualifica di formatori di II livello secondo il Sistema formativo nazionale sul benessere animale del Ministero della Salute.
“Per Unaitalia la formazione continua e rafforzata è il volano per l’evoluzione sostenibile del settore e rappresenta un asset strategico cui dedichiamo risorse ed attenzione. Il benessere degli avicoli è normato a livello europeo e nazionale, ma è la conoscenza diffusa delle buone pratiche a formare la base della cultura dell’allevare bene”, ha dichiarato il presidente di Unaitalia, Antonio Forlini. “La collaborazione con l’IZSAM e la partecipazione di docenti esperti dell’IZSLER e dell’Università di Milano sono la prova che fare rete non solo è possibile, ma è necessario per offrire esperienze formative perfettamente allineate con i bisogni e le esigenze del momento.”
“Siamo molto felici del successo raggiunto da questo momento di formazione”, ha dichiarato Vanni Scarso, Direttore della Business Unit della divisione Livestock di MSD Animal Health Italia. “In MSD Animal Health ci dedichiamo a sostenere l’intera filiera zootecnica. Non solo attraverso la prevenzione, servizi avanzati e tecnologie per sostenere la salute e il benessere animale, ma anche con investimenti concreti in formazione e aggiornamento. Questo impegno ci consente di assicurare a tutti i professionisti del settore un accesso continuo alle più recenti pratiche e conoscenze del campo.”
4 - attualitàATTUALITÀ
Antonio Forlini, presidente di Unaitalia

Box Sanitario
Box per allevamenti, professionale, secondo le normative sanitarie. Robusto, isolato e facile da trasportare.




4 box in un camion completo
Agritech s.r.l.
Via Rimembranze, 7 25012 Calvisano (BS) Italy
Tel. + 39 030 9968222 r.a.
Fax + 39 030 9968444
commerce@agritech.it www.agritech.it

- gennaio 2024 - 5 ATTUALITÀ
Influenza Aviaria, il rischio maggiore è atteso per i prossimi mesi
Nelle ultime settimane sono aumentati i rilevamenti del virus dell’Influenza Aviaria ad alta patogenicità (HPAI) nei volatili selvatici in Europa, ma la crescita è cominciata più tardi rispetto agli anni precedenti, probabilmente a causa del ritardo nella migrazione autunnale di diverse specie di uccelli acquatici.

Nel periodo invernale, con l’aumento della circolazione del virus tra i volatili selvatici, aumenta anche il rischio di focolai di Influenza Aviaria negli allevamenti avicoli: è quanto ha fatto sapere l’EFSA, l’Autorità europea per la sicurezza alimentare, nella sua relazione trimestrale sull’Influenza Aviaria, realizzata insieme al Centro europeo per la prevenzione e il controllo delle malattie (ECDC) e al laboratorio di riferimento dell’UE (EURL).
Tra il 2 settembre e il 1° dicembre 2023 sono stati segnalati focolai di HPAI in uccelli domestici (88) e selvatici (175) in 23 Paesi europei.
Tali risultati sono in linea con le tendenze previste dal Bird Flu Radar dell’EFSA, lo strumento che fornisce previsioni settimanali circa la possibilità che il virus si manifesti negli uccelli selvatici: il sistema di allarme, lanciato a marzo di quest’anno, è facilmente accessibile e, oltre a mappare le migrazioni, è accompagnato da un sistema di messaggistica attraverso il quale gli utenti possono ricevere avvisi automatici per una determinata zona geografica ogni volta che viene superata la soglia di rischio. La relazione ha inoltre rilevato che 7 delle 11 varianti (genotipi) del

virus HPAI identificate in Europa erano nuove e riguardavano diverse specie di uccelli selvatici, in particolare le gru comuni. L’HPAI è stato rilevato per la prima volta in uccelli e mammiferi selvatici nella regione antartica.
Secondo la valutazione compiuta dall’ECDC, il rischio di infezione da virus HPAI in Europa rimane basso per la popolazione in generale e da basso a moderato per le persone che lavorano o che si trovano a contatto con uccelli o mammiferi infetti (sia selvatici che domestici). Per ridurre ulteriormente il rischio di infezione, gli esperti raccomandano di evitare il contatto con uccelli marini o mammiferi morti o malati.
A metà dicembre l’EFSA ha inoltre pubblicato la sua relazione annuale sulla sorveglianza dell’Influenza Aviaria negli avicoli e nei volatili selvatici, che riassume i risultati delle attività di sorveglianza svolte in Europa nel 2022. L’Autorità europea per la sicurezza alimentare a tal proposito ha lanciato un invito a creare una rete di sorveglianza attiva per l’HPAI in tutta Europa.
Fonte: EFSA
6 - attualitàATTUALITÀ








ARTICOLI ACCESSORI
Nastri PP
• Trasporta Uova
• Raccolta Uova
• Essiccazione Pollina
• Raccolta Pollina

4002 H
• Apertura a 360°
• Azione “SOFT”
• Materiale resistente e durevole

4006 H
• Apertura a 360°
• Azione “SUPERSOFT”
• Materiale resistente e durevole



4626
• Adatta per l’ingrasso dei tacchini
• Lettiere asciutte
• Abbeverata in simultanea di 2 e più animali


INFINITY
• Design dalle dimensioni ridotte
• Nessun pulcino nel piatto
• Semplice regolazione del livello di mangime
• Disponibile in versione da gabbia
4901 N
Regolatore di pressione con bypass



Corti Zootecnici Srl | Via Volta, 4 21020 Monvalle (VA) Italy| www.cortizootecnici.it |
per l’allevamento CORTI ZOOTECNICI
Il pollo di razza Romagnola diventa Presidio Slow Food
Il pollo Romagnolo incarna alla perfezione l’allevamento secondo Slow Food, nel quale la vita degli animali, il ruolo dell’uomo e il rispetto dell’ambiente sono strettamente legati.

Un pollo che ha bisogno di spazio
Fino alla metà del secolo scorso, questa razza avicola era diffusa in tutta l’area delle odierne province di Ravenna, Forlì-Cesena e Rimini. Rustico e abile pascolatore, dalla livrea variopinta, il pollo Romagnolo era apprezzato per la duplice attitudine, anzi triplice: innanzitutto per produrre uova, poi per la carne, sapida e saporita e, in alcuni casi, anche semplicemente a scopo ornamentale. “Nell’aia il pollo Romagnolo c’è sempre stato”, ricorda Lia Cortesi, responsabile Slow Food del nuovo Presidio. “Una razza rustica, che ama stare all’aperto, razzolare liberamente”. Eppure, nel secondo dopoguerra, proprio la caratteristica che più lo contraddistingue,
ovvero il bisogno di ampio spazio per procurarsi il cibo raspando tra i ciuffi d’erba e beccando le granaglie avanzate dalla mietitura, ne ha sancito la pressoché totale scomparsa: garantirgli lo spazio all’aperto è diventato, per chi ha preferito adottare un approccio industriale e intensivo all’allevamento, sconveniente e poco redditizio. Non solo: il pollo di razza Romagnola è piuttosto lento a crescere e impiega fino a sei-otto mesi per raggiungere la massa che le razze commerciali toccano in cinquanta o sessanta giorni.
Un Presidio che è un’idea di allevamento
Il processo di recupero, cominciato nel 1997, ha consentito di moltipli-
care il numero di esemplari: “Oggi possiamo stimare tra i 500 e i 600 riproduttori negli allevamenti della Romagna – spiega Alessio Zanon, presidente della Associazione razze autoctone a rischio di estinzione, che si è occupato anche del pollo Romagnolo – più alcuni altri a livello famigliare”. Gli allevatori professionali che aderiscono al Presidio Slow Food sono tre, a cui si aggiungono gli allevatori amatoriali di pollo Romagnolo membri dell’Associazione razze e varietà autoctone romagnole (Arvar). Uno di loro è Davide Montanari, referente dei produttori del Presidio: «Da quasi vent’anni gestisco un piccolo allevamento in cui mi occupo della selezione degli animali destinati a essere i nuovi riproduttori, così da incrementare il patrimonio zootecnico» spiega. Tutti i suoi animali, naturalmente, crescono all’aperto, perché il Romagnolo si esprime al meglio se dispone di ampi spazi erbosi per il pascolo. Come molte altre razze autoctone, anche la Romagnola è meno produttiva: «In realtà è solo incapace di adattarsi a un allevamento intensivo, mentre in un sistema estensivo si rivela vincente» conclude Zanon. «L’allevamento di polli autoctoni dovrebbe essere salvaguardato, non visto in contrapposizione al sistema industriale. I due sistemi non sono in competizione: producono alimenti che provengono sì dalla stessa specie, ma che hanno caratteristiche gustative, salutistiche e qualitative completamente diverse».
Fonte: Slow Food
8 - attualitàATTUALITÀ
©Oliver Migliore


distributoreperl


distributoreperl


distributore per l’Italia

- gennaio 2024 - 9
1969 1969
’Italia
’Italia

Biosicurezza nell’allevamento avicolo: uno strumento efficace per combattere le malattie infettive
Cristina
1 Dipartimento di Medicina Veterinaria e Scienze Animali, Università degli studi di Milano, Via dell’Università 6, 26900 Lodi
2 Dipartimento di Biomedicina Comparata e Alimentazione, Università degli Studi di Padova, Viale dell’Università 16, Legnaro, 35020 Padova
La biosicurezza è l’insieme di pratiche da attuare negli allevamenti avicoli per prevenire l’introduzione e la diffusione di malattie infettive, pertanto rappresenta un potente strumento per proteggere la salute e il benessere degli animali e la sicurezza alimentare. Lo scopo di questo articolo (realizzato nell’ambito del progetto “NetPoulSafe - G.A. 101000728”)
è quello di spiegare in maniera semplice l’importanza della biosicurezza nella gestione delle malattie infettive.
Maria
Rapi1, Laura Musa1, Guido Grilli1, Giuditta Tilli2, Alessandra Piccirillo2
10 - reportageREPORTAGE
Quando si parla di biosicurezza si intende l’insieme di tutte le misure pianificate e poste in atto al fine di prevenire l’ingresso (bioesclusione) e la diffusione (biocontenimento) di agenti patogeni all’interno e tra aziende zootecniche.
Oggi, la biosicurezza rappresenta uno dei più importanti strumenti a disposizione degli allevatori per creare, all’interno della realtà produttiva, condizioni igieniche ottimali, in grado di tutelare la salute e il benessere animale e di fornire garanzie in materia di sicurezza alimentare, impedendo la persistenza in allevamento di agenti di zoonosi a trasmissione alimentare.
La biosicurezza diviene dunque uno strumento gestionale chiave, nonché una parte essenziale, di qualunque sistema di produzione avicola di successo: l’insorgenza di patologie nel pollame, spesso determinate da negligenza o cattiva gestione dell’allevamento, riduce infatti la produttività, la redditività e la sostenibilità finanziaria a lungo termine di qualsiasi realtà produttiva.
Gli agenti patogeni in grado di colpire e di danneggiare seriamente la filiera avicola sono riconoscibili, fondamentalmente, nei virus, nei batteri, nei funghi e nei protozoi; tutti possiedono la capacità e il potere di provocare malattie, che causano consistenti problemi in allevamento, tra i quali la riduzione delle performance produttive dei capi allevati. Per fare degli esempi, gli agenti virali sono responsabili di malattie quali la malattia di Newcastle, la malattia di Gumboro e l’Influenza Aviaria; i batteri sono responsabili dell’insorgenza di patologie quali il Colera Aviario, la Colibacillosi e la Salmonellosi; i funghi determinano problemi di Aspergillosi, di muffe e di micotossine; i protozoi causano, tra gli altri, seri problemi di coccidiosi. Tutti questi patogeni, insieme a pidocchi e acari, rappresentano una grande minaccia per l’allevamento avicolo.
Come riescono questi microrganismi nocivi, pericolosi per il successo produttivo ed economico dell’azienda, a entrare in allevamento?
L’identificazione dei potenziali percorsi attraverso i quali un agente patogeno può essere introdotto in allevamento rappresenta sicuramente il primo, fondamentale passo che produttori e operatori dovrebbero compiere al fine di eseguire una corretta valutazione del rischio, necessaria

Questo è il primo di una serie di articoli tecnici sulla biosicurezza in avicoltura prodotti nell’ambito del progetto Europeo “ NetPoulSafe - Networking European poultry actors for enhancing the compliance of biosecurity measures for a sustainable production (G.A. 101000728). NetPoulSafe è un network tematico dell’Unione europea che si pone l’obiettivo di individuare le migliori misure a supporto della biosicurezza e di stimolare lo scambio delle conoscenze fra i vari attori della filiera avicola europea (Francia, Spagna, Italia, Ungheria, Belgio, Paesi Bassi e Polonia). A questo progetto, in rappresentanza dell’Italia, hanno collaborato la prof.ssa Alessandra Piccirillo e la dott.ssa Giuditta Tilli dell’Università di Padova.
In questo e nei prossimi articoli, che pubblicheremo in febbraio e in marzo, saranno affrontate diverse tematiche (principi di biosicurezza, nuova normativa sulla biosicurezza, biosicurezza in fase di riproduzione e in incubatoio) relative all’attuazione delle misure di biosicurezza nel contesto dell’avicoltura nazionale.
Per maggiori informazioni: www.netpoulsafe.eu All’interno del sito sono disponibili informazioni sul progetto e i materiali di divulgazione prodotti (podcast, video, factsheet, corsi online, manuale sulle misure a supporto, etc.), disponibili in italiano e in altre lingue.
per implementare un programma di biosicurezza appropriato in allevamento.
Le principali vie di diffusione e di ingresso dei patogeni sono rappresentate da:
• trasmissione aerea;
• trasmissione tramite assunzione, da parte dell’animale, di mangime e/o acqua contaminati;
• trasmissione, per contatto diretto, da animali malati, di interesse produttivo o selvatici, ad animali sani;
- gennaio 2024 - 11 REPORTAGE

Università di Padova) nell’ambito del progetto “NetPoulSafe”. Questo progetto è stato finanziato dall’Unione europea, programma Horizon 2020 per la ricerca e l’innovazione, Grant Agreement n. 101000728 (NetPoulSafe). Per maggiori informazioni: www.netpoulsafe.eu
• trasmissione indiretta attraverso attrezzature di allevamento, materiali e veicoli contaminati, o ancora tramite vettori vivi, rappresentati soprattutto da animali infestanti, come roditori, insetti, ma anche da personale e/o visitatori occasionali che non indossano indumenti appositamente predisposti nell’area predefinita.
Le vie di ingresso che i microrganismi possono sfruttare, nonché i percorsi che possono seguire per diffondersi nella realtà produttiva, sono dunque mol-
teplici: da qui la necessità, per ogni allevatore prudente, di adottare, nel proprio allevamento, misure di biosicurezza efficienti, robuste, pratiche al fine di impedire l’introduzione e la circolazione di agenti di malattia, proteggendo sia i propri animali sia la produttività della propria azienda.
Quali sono le procedure di biosicurezza necessarie da attuare per proteggere la propria realtà produttiva?
Le procedure da mettere in atto si collocano a diversi livelli La costruzione di barriere, fisiche e concettuali, diventa la base necessaria per l’implementazione in allevamento di un efficace piano di biosicurezza, costruito in particolare su tre pilastri: segregazione e controllo del traffico di personale e degli automezzi da/ verso l’allevamento, pulizia e disinfezione di strutture e attrezzature.
Gli allevamenti avicoli devono essere progettati in modo tale da impedire l’ingresso di altri animali, sia domestici che selvatici e da limitare l’accesso a persone non autorizzate nelle aree adiacenti ai capannoni (recinzioni, reti antipassero alle finestre). Nello specifico i capannoni devono essere costruiti in modo da impedire l’accesso a uccelli e roditori: tutti i possibili ingressi devono essere sigillati o coperti con rete metallica, la cui integrità deve essere controllata periodicamente. Particolare attenzione deve essere posta a zone di maggior rischio, quali le prese d’aria, gli estrattori, gli scarichi, le finestre, etc. I roditori, ad esempio, sono conosciuti da tempo per essere vettori di infezioni gravi per il pollame quali Sal -
12 - reportageREPORTAGE
Figura 1 – Rappresentazione schematica delle misure di biosicurezza da applicare a livello di allevamento. Immagine realizzata dall’Ufficio Digital Learning e Multimedia (©
monella Typhimurium, Campylobacter, Escherichia coli, Staphylococcus aureus, Pasteurella etc. e quindi il loro ingresso deve essere limitato il più possibile grazie a rigide norme di biosicurezza che comprendono anche il loro controllo.
Anche la lotta agli insetti rientra nelle buone norme di biosicurezza; le mosche, ad esempio, grazie alla peluria che le ricopre esternamente sono in grado di trasportare, sia all’interno che all’esterno dell’allevamento, Salmonella Enteritidis, Campylobacter jejuni, Enterococcus faecium e altri batteri, compresi quelli che hanno un’elevata resistenza agli antibatterici. Analoga funzione può essere attribuita al tenebrione (Alphitobius diaperinus) e all’acaro rosso (Dermanyssus gallinae), molto presenti negli allevamenti di animali a lunga vita. Gli insetti sono anche in grado di mantenere le infezioni tra un ciclo e l’altro se non correttamente controllati, in quanto la durata della loro vita è superiore al periodo di vuoto sanitario, soprattutto nelle stagioni a clima mite.
Di primaria importanza anche la gestione del personale e di eventuali visitatori occasionali: addetti alla cura quotidiana degli animali, veterinari, camionisti, squadre di intervento, manutentori, etc. rappresentano uno degli elementi più importanti nella trasmissione delle malattie all’interno e verso la realtà zootecnica: le visite devono quindi essere ridotte al minimo, permesse solo quando strettamente necessarie e attentamente controllate. Misure di biosicurezza importanti sono quindi rappresentate, tra le altre, dalla predisposizione di una recinzione perimetrale all’allevamento, avente un unico cancello di accesso sempre chiuso e con segnaletica di “divieto di accesso”, rivolto al personale non autorizzato.
Per il personale autorizzato e/o per occasionali visitatori deve essere previsto, ad ogni passaggio tra ‘zona sporca’ (esterna ai capannoni) e ‘zona pulita’ (interna ai capannoni), l’obbligo di lavaggio e disinfezione di, almeno,
ABBEVERAGGIO TACCHINI
EASYLINE 2.0
Costituito da un sistema che ha come elemento principale il pendolo, il quale assicura sempre una perfetta fornitura d’acqua.

• Il pendolo viene azionato ogni qualvolta l’animale lo sposta con la testa per bere.

• Il pendolo con due nipple garantisce una maggiore affidabilità dell’abbeveratoio, sia in termini di durata nel tempo che di semplicità di manutenzione.
• Lettiera più pulita e migliori risultati nel tempo sia nella fase di svezzamento che in quella di ingrasso ad ogni età del tacchino.
Via Marco Polo, 33 - 35011 - Campodarsego (PD) ITALIA +39 0499202290 - lubingsystem.com - info@lubing.it


REPORTAGE
!lanigirO

Figura 2 – Rappresentazione schematica delle misure di biosicurezza da applicare a livello di capannone. Immagine realizzata dall’Ufficio Digital Learning e Multimedia (©Università di Padova) nell’ambito del progetto “NetPoulSafe”. Questo progetto è stato finanziato dall’Unione europea, programma Horizon 2020 per la ricerca e l’innovazione, Grant Agreement n. 101000728 (NetPoulSafe). Per maggiori informazioni: www.netpoulsafe.eu
sottolineare che, all’interno dell’area circostante l’allevamento, devono essere ammessi solo i mezzi il cui accesso si renda indispensabile per le attività produttive; tutti gli altri veicoli devono essere parcheggiati fuori dal perimetro aziendale.
Altre barriere procedurali importanti per prevenire la diffusione di patogeni in allevamento sono rappresentate da un’efficace pulizia e disinfezione di tutte le strutture e le attrezzature, previa attenta rimozione di tutto ciò che è materiale organico, alla fine di ogni ciclo produttivo e prima del ripopola-
mento dell’allevamento: l’obiettivo deve essere quello di abbattere la carica di agenti patogeni eventualmente presenti in ambiente e, conseguentemente, di ridurre al minimo il rischio di insorgenza di problemi sanitari nel ciclo successivo. L’importanza dell’applicazione di un corretto piano di pulizia e disinfezione è fondamentale soprattutto se si sono avuti casi di salmonellosi, in quanto questo batterio è in grado di sopravvivere nella lettiera per diversi mesi. Anche mangiatoie, abbeveratoi e linee di distribuzione idrica devono essere inclusi in questi piani. Periodicamente è necessario procedere anche alla pulizia e disinfezione dei silos del mangime, in quanto possono residuare salmonelle minori che arrivano con l’alimento, nonché micotossine qualora rimanga del mangime tra un ciclo e l’altro. Affinché tali operazioni diano risultati tangibili è necessario che tutti i materiali di costruzione posseggano precisi requisiti, quali facilità di lavaggio, di detersione e di disinfezione. Infine, è importante sottolineare che, per attuare un programma di biosicurezza efficace e di successo, tutte le misure devono essere semplici, comprensibili, conosciute, fruibili, meglio se attraverso apposita cartellonistica collocata in varie zone dell’allevamento, da tutte le persone coinvolte e regolarmente monitorate. Tutti quelli descritti sono aspetti cruciali nelle aziende avicole e, per tale motivo, necessitano di grande attenzione: bisogna infatti ricordare sempre che le malattie in allevamento aumentano notevolmente i costi e le perdite produttive, lasciando l’allevatore con poco o nessun profitto e mettendo potenzialmente a rischio la salute pubblica.
14 - reportageREPORTAGE
TRAMOGGETTA AUTOMATICA PER POLLI DA CARNE
Passaggio automatico dalla fase pulcino alla fase adulta con il sistema a “finestrella”.
Piatto basso utilizzabile dal primo all’ultimo giorno.
Nessun pulcino intrappolato nel piatto.
Piatto studiato per evitare lo spreco del mangime.



- gennaio 2024REPORTAGE
COMPLETAMENTE AUTOMATICA VOGLIO AZA! 1 SECONDO PER APRIRE O CHIUDERE IL PIATTO PER UNA PULIZIA RAPIDA E TOTALE
PRATIKA L’INNOVATIVA
QUALITY MADE IN ITALY www.azainternational.it
Pier Enrico Rossi, Medico veterinario
Daniele Menghi, Tecnico di allevamento

L’apporto di nucleotidi aiuta a prevenire enterite necrotica e coccidiosi
L’apporto di nucleotidi nell’alimentazione favorisce la prevenzione della disbiosi intestinale e, prevenendo l’enterite, crea le premesse per ottenere ottimi indici di conversione insieme a un’elevata longevità produttiva.
Per decenni bacitracina, lincomicina, avoparcina, virginiamicina, tilosina e avilomicina hanno permesso di controllare l’enterite necrotica; successivamente le normative nate per ottenere
16
- dossierDOSSIER
la riduzione degli antibiotici promotori di crescita e degli anticoccidici e ionofori, hanno portato a una recrudescenza di questa malattia.
L’agente eziologico dell’enterite necrotica è il Clostridium Perfrigens, batterio gram-positivo, ubiquitario, anaerobio e sporigeno. Le spore consentono al Clostridium Perfrigens di sopravvivere nei locali d’allevamento per lungo tempo, permettendo la trasmissione a cicli produttivi successivi, rendendo impossibile evitare il contatto tra gli animali e il batterio.
I ceppi di Clostridium Perfrigens variano in virulenza e capacità di causare la malattia, i ceppi patogeni sono in grado di produrre tossine, batteriocine ed enzimi idrolitici che consentono loro di aderire, formare biofilm e colonizzare l’intestino.
Il decorso dell’enterite necrotica può manifestarsi sia in forma clinica che subclinica, la malattia può esordire tra le 2 e le 4 settimane di età: la fase clinicamente manifesta è breve e caratterizzata da depressione, penne arruffate, atassia locomotoria, diarrea, morte in poche ore, con un tasso di mortalità che può raggiungere l’1% al giorno.
La forma subclinica è sicuramente economicamente più dannosa, in quanto può persistere inosservata – e quindi non trattata – con un impatto negativo sull’indice di con-
Il muco dell’apparato gastro-intestinale
Il muco è la prima barriera fisica nei confronti di batteri, altri microrganismi o antigeni nell’intestino. Esso viene prodotto dalle cellule mucipare e ha uno spessore variabile: è più sottile nel tenue, dove c’è un maggiore assorbimento di nutrienti, e più spesso nello stomaco e nel colon, dove ha una maggiore funzione protettiva.

È organizzato in due strati:
• uno esterno, meno denso, dove risiede la normale flora batterica (microbiota);
• uno interno, denso e molto aderente alle cellule epiteliali
versione e sull’uniformità del gruppo. Sebbene sia ampiamente dimostrato che i ceppi patogeni possono alterare la normale microflora intestinale, sostituendosi ai clostridi commensali (non patogeni), per scatenare un’enterite necrotica la sola presenza del Clostridium Perfrigens non è però sufficiente: è indispensabile, infatti, che la parete intestinale presenti già dei danni, poiché questo clostridio produce l’alfa-tossina, una fosfolipasi, enzima mucolitico, che gli permette di nutrirsi di muco. Se a monte della replicazione del clostridio sussiste un evento che provoca l’aumento della secrezione di muco, l’intestino lesionato produce linfociti T, citochine, interferone e interluchine che vanno ad agire sulle cellule caliciformi mucipare dell’epitelio intestinale, attivandole e incrementando la secrezione di muco, rendendo così possibile la proliferazione del Clostridium Perfrigens.
La coccidiosi
Gli agenti capaci di arrecare danni alla mucosa intestinale sono numerosi: virus enterici, elminti, micotossine,

BIOLAB 2000 S.r.l. • Via E. Fermi, 17 • 37060 Lugagnano di Sona (VR)
Tel: 045 86 80 943
• FAX: 045 86 99 707 • Email: biolabvr@tiscalinet.it Biolab 2000 esegue analisi chimiche dei mangimi, nuclei, cereali e foraggi per l’alimentazione animale che prevedono:
• Analisi del cartellino
• Coccidiostatici
• Micro/macroelementi
• Valori nutrizionali
• Analisi multiresiduali
I NOSTRI SETTORI:
• Vitamine
• Micotossine
• Analisi microbiologiche
• Pesticidi

Diagnostica Veterinaria • Agroalimentare • Zootecnico, Analisi chimiche • Biologia molecolare
• PCR-OGM • Analisi delle acque potabili e di scarico
17 - gennaio 2024DOSSIER
www.biolab2000.it
ammine biogene, rancidità del grasso, stress, ma la patologia più diffusa è la coccidiosi del duodeno e del digiuno, provocata da Eimeria maxima ed Eimeria acervulina, che causano con maggior frequenza danni all’intestino dei broiler.
La coccidiosi può manifestarsi a causa dell’aumento della resistenza ai coccidiostatici oppure in seguito all’utilizzo di vaccini vivi contro la coccidiosi: questi vaccini sono composti da specie di Eimeria non attenuate o poco attenuate, che devono invadere la mucosa intestinale e moltiplicarsi, ma che per provocare un’immunità solida hanno bisogno di tre cicli di infezione consecutivi, rischiando di provocare un danno epiteliale.
Per controllare la coccidiosi e ridurre l’incidenza dell’enterite necrotica è necessaria una corretta rotazione dei farmaci anticoccidici, per preservarne l’efficacia. Intervenire con la rotazione tra farmaci e vaccinazione, in base ai livelli di rischio e all’incidenza stagionale, insieme a una corretta gestione della pulcinaia, per promuovere un’adeguata ciclizzazione delle oocisti, è fondamentale per evitare effetti avversi e predisporre l’allevamento alla manifestazione dell’enterite necrotica.
La capacità di alcuni polifenoli, associati a estratti vegetali e a sali minerali, si è dimostrata efficace nel ridurre la carica batterica della lettiera dopo l’escrezione fecale: questo potrebbe essere uno strumento prezioso per ridurre la probabilità di reinfezione da Clostridium Perfrigens.
Per prevenire le alterazioni che possono predisporre gli animali all’enterite necrotica si è diffuso l’impiego di probiotici per bilanciare la microflora intestinale: è stato infatti dimostrato come alcuni ceppi di lattobacilli – sia usati da soli che insieme ad acidi organici (formico, propionico e butirrico) per potenziare il loro effetto – riducono la gravità delle lesioni da enterite emorragica e la conseguente mortalità.
Altri prodotti alternativi, quali i MOS o beta-glucani, hanno dimostrato la capacità di ridurre la gravità delle lesioni causate dall’enterite necrotica grazie ai loro effetti antinfiammatori, perché favoriscono la secrezione di immunoglobuline e la produzione di acidi grassi a catena corta (SCFA). Occorre ricordare che il Clostridium Perfrigens, come altri patogeni enterici, è un microrganismo altamente adattabile, pertanto è necessario utilizzare questi prodotti in modo equilibrato per evitare il manifestarsi di fenomeni di resistenza.
L’utilizzo di nucleotidi
Una nuova promettente opportunità è rappresentata dall’impiego dei nucleotidi.
Il termine nucleotide descrive una sostanza costituita da uno zucchero, un gruppo fosfato e una base azotata; le basi sono purine e pirimidine, lo zucchero è il ribosio o il desossiribosio. Nel suo insieme il nucleotide rappresenta l’unità con la quale si forma l’RNA e il DNA; inoltre i nucleotidi sono anche i costituenti delle molecole quali ATP, NADP e NADH, responsabili di trasferire l’energia prodotta dal metabolismo di carboidrati, lipidi e proteine.
In quanto sintetizzabili dall’organismo animale, i nucleotidi non sono considerati un alimento essenziale ma lo diventano in caso di una sintesi insufficiente, durante la crescita e in presenza di patologie. In particolare, alcuni tessuti a rapido turn-over, come quelli della mucosa intestinale, non sono in grado di produrre quantità sufficienti di nucleotidi tali da coprire i loro fabbisogni. È stato dimostrato che i nucleotidi apportati con l’alimentazione agiscono come fattore di crescita sulle cellule intestinali, promuovendone la differenziazione e la maturazione, con conseguente maggior spessore della mucosa intestinale, con allungamento dei villi e della profondità delle cripte.
Diversi studi hanno dimostrato che l’apporto di nucleotidi con l’alimentazione favorisce l’incremento dell’attività degli enzimi digestivi e promuove la crescita dei Lattobacilli e dei Bifidobatteri, a scapito dei batteri Gram-negativi quali Escherichia coli. Il favorevole effetto dei nucleotidi su Lattobacilli e Bifido-batteri si pensa sia dovuto all’aumento dell’assorbimento di oligoelementi in forma ionica, da parte degli enterobatteri.
L’apporto di nucleotidi si è inoltre dimostrato molto utile nel recupero clinico e funzionale delle affezioni epatiche: questo accade perché essi promuovono l’attività dell’epatocida, attraverso la stimolazione mitocondriale atta a favorire la produzione di sirtuine, accelerando la sintesi proteica e il deposito di glucosio, impedendo in questo modo l’accumulo di colesterolo e altri lipidi e riducendo il rischio di steatosi epatica. In tal modo essi esercitano un’azione estremamente favorevole all’allungamento della vita produttiva degli animali, in particolare della gallina ovaiola.
Se è vero che i nucleotidi non sono considerati essenziali perché possono essere sintetizzati da sostanze semplici, è altrettanto vero, tuttavia, che in alcuni momenti i pro -
18 - dossierDOSSIER
cessi metabolici di sintesi possono non essere in grado di soddisfarne il fabbisogno: ciò accade, per esempio, durante i periodi di rapido ricambio cellulare, come il normale processo di accrescimento del pulcino, che nei primi sette giorni di vita (di cui i primi tre definiscono gran parte delle sue prestazioni successive) cresce di circa il quadruplo.
Sebbene la natura fornisca al pulcino le sostanze nutritive attraverso il residuo del sacco vitellino, questa riserva alimentare ha solo il fine di evitare che il pulcino muoia di fame, ma è assolutamente insufficiente per affrontare le difficoltà e lo stress dei primissimi giorni di vita.
Poter disporre di una fonte di nucleotidi solubili derivati dall’estrazione di lieviti ne permette la somministrazione sia in acqua d’abbeverata che nel mangime, fin dalle primissime ore di vita e consente al pulcino di raggiungere il suo massimo potenziale di crescita, attraverso un corretto accrescimento dell’apparato enterico e del suo corretto microbiota.
I vantaggi si evidenziano subito: si riscontra una minor collosità delle feci nei primi giorni di vita e una ridotta incidenza di bottoncini anali. Anche la lettiera risulterà più asciutta nei primi giorni, evidenziando una netta riduzione della pododermatite (FPD, Foot pad dermatitis); inoltre la crescita evidenzierà un’omogeneità del gruppo con un migliore indice di conversione.
I vantaggi finora elencati sono particolarmente evidenti nei broiler, mentre nell’allevamento di animali a lunga vita, come la gallina ovaiola, i vantaggi deriveranno da un maggior benessere intestinale, dal ripristino dell’attività epatica e dalla capacità dei nucleotidi, una volta entrati in una cellula, di dare origine al NAD (nicotinammide adenina dinucleotide, molecola indispensabile per l’attività di più di 500 enzimi, tra cui le sirtuine, la cui carenza è la causa dell’invecchiamento). Tutto questo si tradurrà in un miglior indice di conversione, una minore percentuale di uova sporche, una riduzione della fragilità del guscio e il prolungamento dell’attività produttiva.


BLUE FAN
STRUTTURE AVICOLE
Progettazione e realizzazione chiavi in mano ARCHI DISINFETTANTI
Sistemi personalizzati per la disinfezione dei mezzi in ingresso
ATTREZZATURE
Sistemi per allevamento carne e ventilazione ASSISTENZA
MAGAZZINO RICAMBI

Materiale anticorrosivo
Alte prestazioni, Risparmio energetico
CENTRALINE DI CONTROLLO
Analisi, ottimizzazione e gestione automatica dell’allevamento

CAPPE RADIANTI
Sistemi




NIDI E VOLIERE

Attrezzature per ovaiole da consumo
RACCOLTA UOVA
Sistemi automatici raccolta e imballaggio uova
NIDI RIPRODUTTORI
Attrezzature per riproduttori da cova

19 - gennaio 2024DOSSIER
TECNOLOGIE AVANZATE per L’AVICOLTURA
MBE srl | Via delle Fornaci 88/A, Fabriano (AN) www.mbefabriano.it
|
+39 0732 627167 | Facebook @MBESRL2013 | Instagram @mbe_srl
di riscaldamento a infrarossi ad alta efficienza
Rivenditore per l’Italia di:

Gestione della lettiera del pollo
Tom Tabler, Professor, Department of Animal Science, University of Tennessee
Per ridurre la suscettibilità dei polli alle malattie infettive, l’ambiente del capannone gioca un ruolo chiave nel sostenere il sistema immunitario e la salute del gruppo. L’efficienza delle produzioni avicole e il benessere animale sono infatti notevolmente influenzati dalle condizioni interne. Un fattore critico, che condiziona direttamente le performance e il benessere, è proprio la gestione della lettiera.
©Popular science
Xuan Dung Nguyen, Graduate Research Assistant, Department of Animal Science, University of Tennessee
20 FOCUS - focus -
Gli USA sono tra i maggiori produttori avicoli mondiali, in particolare per la carne di pollo e tacchino e per le uova di gallina: insieme, il loro valore nel 2020 ha superato i 35 miliardi di dollari. La produzione avicola, che fornisce agli americani una fonte di proteine a buon mercato e da cui trae sostentamento circa 1 milione di persone, viene esportata per circa il 18%. In Tennessee la produzione di pollo è la principale nel settore avicolo.
L’industria avicola sta affrontando diverse sfide, tra cui l’impatto delle malattie infettive e una crescente richiesta di miglioramento degli standard di benessere. Un aspetto cruciale che influenza le performance avicole e il benessere è proprio la gestione della lettiera, in particolare il controllo della sua umidità e quello dell’ammoniaca, la sua profondità e il tipo di materiale di cui è composta. Mantenere una lettiera di buona qualità è un costante problema per la produzione, anche perché recentemente sono stati attuati molti programmi di produzione senza antibiotici (NAE, No Antibiotics Ever).
Problemi nel riutilizzo della lettiera
Riutilizzare la lettiera nella produzione avicola è una pratica comune ed economica; però il riutilizzo per diversi gruppi consecutivi può causare problemi, se non viene gestito in modo appropriato. Questa pratica, infatti, comporta che le problematiche del gruppo precedente, come alti valori di ammoniaca volatile, presenza di malattie o elevato contenuto di umidità, possono facilmente ricadere sul gruppo successivo. In particolare, riuscire a mantenere una buona qualità dell’aria in presenza di lettiera riciclata può diventate un serio problema.
Il prezzo elevato e la diminuita disponibilità di materiale di buona qualità aumentano i problemi legati alla lettiera vecchia. I trucioli di pino costituiscono il materiale ideale, ma altri mercati li stanno richiedendo, e ciò ne fa aumentare il prezzo, rendendo difficile per i produttori avicoli riuscire ad approvvigionarsi. Per questo motivo l’industria avicola sta cercando alcuni materiali alternativi, come il miscanto. Un altro possibile materiale per la lettiera, in futuro, potrebbe diventare la canapa: essa infatti – data la sua struttura naturalmente ripiegata – assorbe fino a 4 volte il proprio peso e quindi mostra un elevato tasso di assorbimento dell’umidità e una altrettanto buona capacità di rilasciarla; costa però più dei trucioli e finora mancano dati sulle sue rese, pertanto è ancora difficile utilizzarla come alternativa.
Un altro problema che si verifica in presenza di lettiera ricostituita è quello dello sviluppo di patogeni. Tipicamente, le condizioni ottimali per la crescita del pollo sono le stesse che favoriscono lo sviluppo dei patogeni, pertanto una cattiva gestione della lettiera riutilizzata può comportarne una crescita eccessiva. I produttori devono ridurre le cariche di patogeni al di sotto della pressione di malattia tollerabile dal gruppo.
Contenuto di umidità
Il fattore fondamentale che influenza la qualità della lettiera è l’umidità: essa è a sua volta influenzata da diversi fattori (temperatura, umidità dell’aria, ventilazione) e dalle proprietà della lettiera medesima (tipo di materiale, suo eventuale riutilizzo, profondità e contenuto iniziale di umidità). Un cattivo controllo dell’umidità causa gravi dermatiti plantari (Figura 1) che diminuiscono le rese e il benessere.


Studi sull’argomento raccomandano un livello massimo del 25% di umidità: se lo si supera, aumenta anche la concentrazione di ammoniaca nei capannoni, che a sua volta condiziona salute e benessere. Mantenere la concentrazione di ammoniaca al di sotto del 25% però non sempre è possibile, specialmente durante l’inverno. Determinare esattamente quanta umidità sia presente nella lettiera del pollo richiede l’assistenza di un laboratorio: i campioni vengono raccolti da diversi punti del capannone e un campione composito viene poi inviato al laboratorio per le analisi. Il materiale viene prima pesato, poi, dopo un processo di essiccamento che di solito dura 24 ore, viene nuovamente pesato: la perdita di peso indica la quantità di acqua perduta e da questo dato si calcola il contenuto iniziale di umidità. Una maniera alternativa di misurare l’umidità è la pratica descritta da Michael Czarick nel 2007, che consiste nello stringere in mano una manciata di lettiera:
• se resta a forma di palla, la lettiera è troppo umida;
• se aderisce leggermente, l’umidità è accettabile;
- gennaio 2024 - 21 FOCUS
Figura 1 – Dermatite plantare causata dalla lettiera.
• se invece non resta compatta e si sfalda, è troppo secca.
Gli allevatori dovrebbero controllare l’umidità regolarmente. Riutilizzare la lettiera avicola di gruppi precedenti anche per il gruppo successivo è garanzia di un costante aumento dell’umidità, causato dalla respirazione e dalle feci emesse; per compensare questo aumento, i sistemi di ventilazione vanno mantenuti in maniera corretta, specialmente durante l’inverno.
Produzione senza antibiotici (NAE)
Questa tipologia produttiva richiede una gestione della lettiera ancora migliore, sebbene si sia visto spesso che in questo tipo di produzione la lettiera riutilizzata potrebbe dare più vantaggi: da un lato, infatti, essa potrebbe portare a sviluppare più malattie, ma dall’altro, se il produttore gestisce bene la lettiera vecchia e mantiene un buon microbiota, può rappresentare un beneficio per i broiler. Produrre senza antibiotici significa che i polli non godono più dello scudo protettivo degli antibiotici, pertanto la gestione della lettiera è ancora più importante: occorre evitare che in essa si sviluppino patogeni, perché i polli sono più esposti alle malattie.
Il controllo delle malattie e la gestione dei morti sono aspetti importanti che l’allevatore di polli NAE deve considerare. Nella produzione senza antibiotici si è imparato a gestire, gradualmente, una serie di problematiche e le relative soluzioni, consone a una produzione che non usa antibiotici, come:
• densità di accasamento ottimale;
• buona gestione della lettiera;
• ambiente del capannone ideale;
• mangime pre-starter di qualità;
• buona qualità dell’acqua ed efficace programma di sanificazione idrica.
Gestione della lettiera in inverno
Alcuni problemi nei mesi invernali derivano dalla presenza di aria fredda esterna, con una pulcinaia attorno ai 32 °C, una ventilazione minima, che rende la distribuzione uniforme della temperatura difficile, e il costo elevato del propano, che va bruciato per mantenere il gruppo al caldo. Nel corso dell’inverno i produttori devono trova-
re un equilibrio tra le spese del riscaldamento e il mantenimento della ventilazione necessaria per rimuovere ammoniaca e umidità. Errori nell’equilibrio tra perdita di calore e ventilazione significano:
• elevate concentrazioni di NH3;
• aumento dei patogeni e rischio di malattie;
• elevate concentrazioni di umidità nella lettiera.
L’umidità è il fattore chiave che influenza la qualità della lettiera durante l’inverno. Le fonti principali dalle quali deriva sono due: la prima fonte è rappresentata dai polli. Essi consumano circa 1 kg di acqua per ogni mezzo kg di mangime assunto; l’80% dell’acqua assunta ritorna poi nell’ambiente in forma di feci e respirazione. La seconda fonte è rappresentata dalle cappe: per ciascun litro di propano bruciato vengono infatti prodotti 0,8 kg di acqua. L’allevatore deve pertanto controllare questa umidità con la ventilazione e la quota di aerazione varia costantemente. Il tasso di ventilazione è necessario per mantenere il livello di ammoniaca a meno di 25 ppm e l’umidità relativa tra il 50 e il 70%.
Controllo dei patogeni
In inverno, quando ammoniaca e umidità sono poco controllate, la concentrazione dei patogeni nella lettiera aumenta. Per risolvere questo problema, esistono alcune soluzioni:
• la pastorizzazione, che usa il caldo per uccidere i patogeni;
• il compostaggio, metodica ben conosciuta;
• il rimescolamento in pile, detto andanatura, che è un modo affidabile ed economico per ridurre le cariche patogene. Non è un vero e proprio compostaggio, perché richiede un tempo inferiore, ma il calore che si sviluppa nelle file di lettiera ammucchiata, se la tecnica è eseguita correttamente, riesce comunque a uccidere la maggior parte dei patogeni.
L’andanatura può essere difficile da gestire (Figura 2): per fare un esempio, l’umidità deve essere tra il 25 e il 30%, altrimenti le pile non si riscaldano adeguatamente e, se ciò non accade, il processo non apporta alcun beneficio, con una perdita di tempo e di gasolio. Bisogna poi calcolare un sufficiente periodo di interciclo per una corretta andanatura: se, con il giusto livello di umidità, si concede alle pile tempo sufficiente per raggiungere la temperatura di circa 60 °C, la maggior parte dei patogeni
22 FOCUS - focus -
viene inattivata. In base al contenuto dell’umidità potrebbe essere necessario lasciare la lettiera crostosa sul posto, per avere abbastanza umidità da fare partire il processo termico dell’andanatura: chiedete al vostro tecnico se sia o meno il caso di usare le croste prima di andanare.


La prima impilatura andrebbe fatta due giorni dopo il carico e lasciata lì per tre giorni. Poi si deve rigirare la prima fila per farne una seconda, che resta ugualmente ferma per altri 3 giorni; infine la si livella e la si lascia asciugare per 4 giorni, mentre si raffredda, applicando anche un ammendante (in caso contrario, la quantità di ammoniaca emessa dalla lettiera potrebbe rapidamente superare la capacità assorbente dell’ammendante, rendendolo inefficace). Una lettiera più profonda di 15 centimetri è inoltre più difficile da ammendare, per la quantità di materiale presente nel capannone: l’andanatura lavora al meglio con lettiere tra i 9 e 15 centimetri.
Trattamenti della lettiera
Per una corretta andanatura è necessario che tra un gruppo e il successivo ci sia abbastanza tempo: meno di 10 giorni non consentono infatti una maturazione della lettiera. Specialmente dopo avere andanato, è importante usare i trattamenti idonei a gestire i livelli di ammoniaca.
Alcuni ammendanti riescono anche a ridurre la carica di patogeni; altri però aumentano il contenuto di azoto della lettiera, così la conversione dell’azoto in ammoniaca pone problemi ambientali. L’ammoniaca infatti è un grande rischio, sia per il benessere animale che per l’economia dell’industria avicola e va pertanto gestita bene. Molti degli ammendanti della lettiera sono acidificanti e gli allevatori devono seguire le indicazioni del produttore, rispettando le linee guida che indicano le precauzioni per un uso sicuro.
Di solito i trattamenti comprendono:
• sodio bisolfato;
• solfato di alluminio;
• particelle simili a creta immerse in acido solforico;
• solfato di ferro;
• acido solforico e solfato di alluminio.


- gennaio 2024 - 23 FOCUS
Figura 2 – Andanatura in capannoni avicoli.
ORIGINAL ATTREZZATURE AVICOLE ® »VARIA CON NIDO CENTRALE« PRODUTTORE DI ATTREZZATURE AVICOLE DAL 1961! Raccolta delle uova dal nido centrale! Le uova vengono raccolte automaticamente. Eccellente veduta su ogni piano! I nastri della pollina stretti garantiscono un ottimo scorrimento! La profondità dell’impianto fino al centro è quanto un braccio!
di appoggio accessibile! Nidi che garantiscono il benessere degli
Essiccazione della pollina su richiesta del cliente! D-47665 Sonsbeck/Germany • Dassendaler Weg 13 Telefon +49 (0) 2838 912-0 • Fax: +49 (0) 2838 2791 www.specht-tenelsen.de • info@specht-tenelsen.de Carmen Lanzellotti +49 02838 912 0 lanzellotti@specht-tenelsen.de Hans Theo Ten Elsen GSM: +49.173-8 79 65 82 GmbH & Co. KG
Griglia
animali!

Disposizione interna dei capannoni
Ammoniaca, umidità, temperatura e diossido di carbonio sono fattori critici che influenzano la produzione avicola e il benessere animale.
Per valutare propriamente questi parametri, gli allevatori devono acquisire strumenti di misurazione quali sensori di umidità e di ammoniaca. In certi casi gli allevatori vengono esposti all’ammoniaca per lunghi periodi e potrebbero quindi non riuscire più a rilevare livelli critici del gas nel capannone, diversamente da chi non ci lavora. In ogni caso queste strumentazioni vanno considerate come supporto e non devono sostituire l’allevatore nella corretta conduzione aziendale: nulla funziona meglio dei sensi umani.
Alcuni autori promuovono il metodo del “secchio da 20 litri” come miglior sistema per valutare l’ambiente interno del capannone. In sostanza il sistema si attua in questo modo: occorre sedersi su un secchio e guardare i polli, osservare come rispondono a condizioni ideali, imparando come si comportano quando hanno caldo, freddo, ecc.
Se si impara a riconoscere cosa comunicano gli animali, sono essi stessi che possono dirci cosa non funziona e ciò lo si impara solamente restando nel capannone, perché tutti i controlli automatizzati non possono comunque allevare i polli al posto dell’allevatore: possono assisterlo, ma deve essere sempre l’allevatore a fare il suo mestiere, e il solo modo di farlo è quello di stare dentro al capannone.
Riassunto
Al termine di queste considerazioni, i messaggi da tenere presenti sono essenzialmente due:
• l’umidità della lettiera e il livello di ammoniaca sono critici nel mantenere produttività e benessere;
• la produzione senza antibiotici (NAE) ha reso la gestione della lettiera ancora più critica di quanto già non fosse.
La bibliografia è disponibile su richiesta
Per gentile concessione della University of Tennessee Institute of Agriculture and UT Extension.
24 FOCUS - focus -
Proiettati Verso Prestazioni d'Eccellenza.

Per una persistenza in costante aumento scegli Hy-Line! Produzioni oltre il 90% sempre più a lungo!

CONCORRENTE 1
CONCORRENTE 2
Email: info@hylineitalia.com – Tel.: +39 0141 907087
Dinamiche e
modelli
del commercio di carne avicola tra il 2012 e il 2022 negli Stati Uniti
Il Brasile, gli Stati Uniti e alcuni Stati membri dell’UE dominano il commercio mondiale di carne avicola. Fino al 2007 gli Stati Uniti erano in testa nelle esportazioni di carne di pollo, poi hanno lasciato la prima posizione al Brasile. Nel commercio di carne di tacchino sono invece ancora al primo posto, ma hanno perso quote di mercato dalla metà dell’ultimo decennio a favore di Polonia, Germania, Italia e Spagna. Come spiega l’articolo, i massicci focolai di Influenza Aviaria nel 2015 e nel 2022 hanno svolto un ruolo importante nella dinamica e nei modelli statunitensi del commercio di carne avicola.

Carne di pollo, stabile il volume con perdita di quote di mercato
Hans-Wilhelm Windhorst
Professore Emerito all’Università di Vechta, Germania
Ad eccezione del 2015, gli Stati Uniti hanno esportato oltre 3 milioni di tonnellate di carne di pollo. La Figura 1 mostra come nella maggior parte degli anni il volume abbia addirittura superato i 3,3 milioni di tonnellate. Il valore delle esportazioni ha tuttavia oscillato da soli 2,8 miliardi di dollari nel 2015 a quasi 4,3 miliardi di dollari nel 2022. Questa fluttuazione riflette la dinamica del valore medio per tonnellata esportata.
Nel 2015 i focolai di Influenza Aviaria han-
no colpito principalmente le aziende di uova e tacchini in Minnesota e Iowa, riducendo notevolmente il loro volume di produzione. Sebbene non si siano verificati focolai nel centro della produzione di carne di pollo nel Sud-Est, il volume delle esportazioni è diminuito di quasi 443.000 tonnellate tra il 2014 e il 2015 e ci sono voluti diversi anni prima che il volume precedente fosse nuovamente raggiunto. Tale declino è stato il risultato del divieto di importazione di carne avicola americana stabilito da 30 Paesi. La quota delle esportazioni è scesa dal 14,3% del 2014 all’11,9% del 2015.
26 - marketing -
MARKETING
La Tabella 1 documenta le esportazioni verso i dieci principali Paesi di destinazione nel 2014, 2015 e 2022. A causa dei focolai, Russia e Cina non hanno permesso alcuna importazione nel 2015, le esportazioni in Angola sono diminuite di 90.000 tonnellate (pari al 39%), quelle a Cuba di 38.000 tonnellate (26%). Al contrario sono aumentate le esportazioni verso Hong Kong, Vietnam e Canada. Il valore per tonnellata esportata di carne di pollo è diminuito del 15% tra il 2014 e il 2015 e addirittura del 23% nel 2016: tale forte calo è il risultato del prolungato divieto da parte di diversi Paesi e di un surplus sul mercato mondiale. Il basso prezzo medio sul mercato globale è stato una conseguenza della pandemia di Covid-19: la chiusura di ristoranti e punti vendita del sistema alimentare non solo negli Stati Uniti, ma anche in molti altri Stati, ha causato un eccesso di offerta e ha costretto le società esportatrici ad accettare prezzi più bassi. Il valore medio per tonnellata è diminuito da 1.226 $ nel 2014 a 1.046 $ nel 2015 e 946 $ nel 2016.
Nel 2021 e nel 2022 il volume delle esportazioni è rimasto stabile nonostante l’epidemia di Influenza Aviaria del 2022, ma è di nuovo diminuito nel primo trimestre del 2023 a causa dei divieti di importazione. Vale la pena notare che il valore delle esportazioni è comunque aumentato di 520 milioni $ nei due anni considerati insieme. I focolai di Influenza Aviaria che hanno colpito Europa e Asia hanno provocato una situazione di mercato tesa, che ha fatto aumentare i prezzi: il valore per tonnellata esportata di carne di pollo è salito da 1.127 $ nel 2021 a 1.295 $ nel 2022. La Russia, che è stata un notevole importatore nel
Valore medio
Figura 1 – Sviluppo delle esportazioni americane di carne di pollo per volume e per valore tra il 2012 e il 2022 (design: A.S. Kauer sulla base di dati USDA e FAS).
2014, negli anni successivi non compare più tra i primi dieci Paesi di destinazione a causa del divieto di esportazione stabilito nel 2014: tale divieto può considerarsi un fattore, ma lo è altrettanto il notevole progresso dell’indu-
Tabella 1 – Contributo dei principali dieci Paesi di destinazione delle esportazioni americane di carne di pollo nel 2014, 2015 e 2022; dati in migliaia di tonnellate (fonte: USDA, FAS).
27 - gennaio 2024MARKETING
Paese Export Contributo (%) Paese Export Contributo (%) Paese Export Contributo (%) Messico Angola Canada Cuba Russia Cina Taiwan Hong Kong Iraq Georgia 695.7 230.9 162.8 143.7 138.2 118.0 115.2 104.9 88.5 87.8 21.0 7.0 4.9 4.3 4.2 3.6 3.5 3.2 2.7 2.6 Messico Canada Taiwan Angola Hong Kong Cuba Guatemala Vietnam Iraq Filippine 668.1 181.3 174.5 140.7 132.6 105.9 104.2 77.2 73.3 71.7 23.3 6.3 6.1 4.9 4.6 3.7 3.6 2.7 2.6 2.5 Messico Cuba Taiwan Filippine Angola Canada Cina Guatemala Vietnam Congo francese 663.8 272.7 236.6 188.8 178.3 151.4 138.6 128.4 116.9 83.9 20.1 8.3 7.2 5.7 5.4 4.6 4.2 3.9 3.5 2.5 10 Paesi 1,885.7 57.0 10 Paesi 1,729.5 60.3 10 Paesi 2,159.4 *65.4 Totale 3,309.9 100.0 Totale 2,867.0 100.0 Totale 3,301.3 100.0
2014 2015 2022
[bill. $] 0,0 1,3 2,5 3,8 5,0 [mil. t] 2,5 2,8 3,0 3,3 3,5 20122013201420152016201720182019202020212022 Volume di Export Valore di Export [$/t] 100 400 700 1.000 1.300 20122013201420152016201720182019202020212022
* il totale non aumenta per l’arrotondamento
stria russa dei broiler, che non solo ha raggiunto la piena autosufficienza, ma ha anche permesso di esportare. Sebbene le esportazioni abbiano raggiunto nel 2022 lo stesso volume del 2012, gli Stati Uniti hanno perso quote di mercato nel commercio mondiale di carne avicola. Nel 2012 gli USA avevano contribuito al volume mondiale delle esportazioni con il 28,5%; la quota è scesa al 24,3% nel 2021 e, secondo i dati preliminari, a solo il 21,2% nel 2022.
Focolai di Influenza Aviaria e carne di tacchino: peggio le esportazioni della produzione
La produzione di carne di tacchino ha oscillato tra 3,39 milioni di tonnellate nel 2012 e 2,99 milioni di tonnellate nel 2022. Nel 2015 più di 160 focolai negli allevamenti di tacchini hanno provocato una perdita di 7,5 milioni di animali, morti a causa dell’infezione o abbattuti per impedirne la diffusione. La produzione è diminuita da 3,30 milioni di tonnellate nel 2014 a 3,17 milioni di tonnellate nell’anno successivo (4,0%). La diminuzione relativa può essere sorprendentemente bassa, ma dato che la maggior parte dei focolai si è verificata nella prima metà dell’anno, le aziende sono state rifornite dopo molte settimane di quarantena e la produzione è stata riavviata ex novo (Windhorst 2016).
La situazione è stata diversa nel 2022: i 217 focolai si sono diffusi durante tutto l’anno e hanno causato una perdita di 9,7 milioni di capi, in parte perché infetti, in parte perché abbattuti a scopo preventivo. La produzione di carne di tacchino è dunque diminuita da 3,23 milioni di tonnellate nel 2021 a 2,99 milioni di tonnellate nel 2022, con un calo pari al 7,4% (Windhorst 2023).
La Figura 2 documenta l’andamento del volume delle esportazioni, il loro valore e il prezzo medio per tonnellata che potrebbe essere raggiunto sul mercato mondiale. L’epidemia di Influenza Aviaria nel 2015 e il divieto di importazione di carne avicola, come pronunciato da 30 paesi, hanno provocato un calo del volume delle esportazioni da 351.400 t nel 2014 a 239.900 t nel 2015 o del 31,7%.
La quota delle esportazioni nel volume di produzione è scesa dal 10,6% al 7,6%. Il valore delle esportazioni è diminuito da 766,3 mill. $ a 589,0 mill. $ o del 23,1%. La minore quota relativa del valore delle esportazioni rispetto al loro volume è una conseguenza della situazione del
Figura 2 – Sviluppo delle esportazioni americane di carne di tacchino per volume e per valore tra il 2012 e il 2022 (design: A.S. Kauer sulla base di dati USDA e FAS).
mercato e dei prezzi più elevati della carne di tacchino sul mercato internazionale. Il valore medio per tonnellata è aumentato da 2.181 $ a 2.455 $; negli anni successivi il prezzo medio è sceso di nuovo a 2.160 $ nel 2017.
I focolai del 2022 hanno avuto un impatto massiccio sul volume e sul valore delle esportazioni. Il diverso andamento temporale dell’epidemia e i perduranti divieti sulle importazioni di carne americana di tacchino si riflettono nel calo del volume delle esportazioni, passate da 248.400 tonnellate nel 2021 a 184.800 tonnellate nel 2015 (pari al 25,6%). Al contrario, il valore delle esportazioni è diminuito di soli 23,9 milioni $ (3,6%). La differenza è il risultato del forte aumento del valore medio per tonnellata da 2.340 $ a 3.479 $ a causa della situazione serrata del mercato non solo su quello interno ma anche su quello mondiale. Con solo il 6,2%, le esportazioni nel 2022 hanno avuto la quota più bassa della produzione da anni. Anche nel primo trimestre del 2023 il volume e
28 - marketingMARKETING
[mil. $] 0 200 400 600 800 [1.000 t] 0 100 200 300 400 20122013201420152016201720182019202020212022 Volume di export Valore di Export [$/t] 0 1.000 2.000 3.000 4.000 20122013201420152016201720182019202020212022 Valore medio
il valore delle esportazioni sono stati inferiori rispetto al quarto trimestre del 2021.
Notevoli fluttuazioni nella classifica dei principali Paesi di destinazione
Le due epidemie di Influenza Aviaria nel 2015 e nel 2022 hanno avuto un impatto considerevole sulla composizione e sulla classifica dei principali Paesi di destinazione. La Figura 3 documenta le modifiche tra il 2014 e il 2015 e quelle tra il 2021 e 2022. Nel 2015 il Messico è rimasto saldamente al comando della classifica, nonostante una riduzione delle importazioni di 73.300 tonnellate, pari al 32,4%, mentre la quota delle esportazioni negli Stati Uniti è rimasta stabile. Le importazioni cinesi sono diminuite da 25.752 tonnellate nel 2014 a solo 289 tonnellate nel 2015: quando sono stati documentati i primi focolai di Influenza Aviaria negli Stati Uniti, infatti, la Cina ha immediatamente chiuso i suoi confini. Questa drastica riduzione delle importazioni è stata in qualche misura compensata da un aumento delle importazioni di Hong Kong di 4.500 tonnellate.
Un dato sorprendente riguarda il Giappone, che nel 2015 ha importato circa 1.200 tonnellate in più rispetto all’anno precedente, mentre di solito il Paese pone un divieto di importazione non appena un caso di Aviaria è documentato nel Paese di origine; forse la carne proveniva da scorte gestite dagli USA in Asia per continuare a rifornirsi proprio in caso di un’epidemia di IA. Ad eccezione del
Gabon e di Panama, tutti gli altri Paesi del gruppo hanno ridotto considerevolmente le proprie importazioni, alcuni, come le Filippine e il Benin (Tabella 2) anche in modo considerevole. L’epidemia di Influenza Aviaria nel 2022 ha causato una diminuzione delle esportazioni di carne di tacchino di 63.563 tonnellate (25,6%). Il più alto calo assoluto è stato registrato in Messico con 39.000 tonnellate, in Repubblica Dominicana con 3.100 tonnellate, in Benin con 3.000 tonnellate e in Cina con 2.000 tonnellate. Il più alto calo relativo è quello della Repubblica Dominicana con il 52,9%, cui segue la Cina con il 32,7% e il Benin con il 32,6%. Canada e El Salvador invece hanno fatto registrare un volume delle importazioni stabile, se non addirittura in aumento. La Figura 3 documenta la forte dipendenza degli Stati Uniti dall’industria messicana del tacchino: nel corso dell’intero decennio in esame la quota che il Messico ha occupato nelle esportazioni degli Stati Uniti varia tra il 60% e il 70%. Un ruolo importante lo hanno giocato anche altri Paesi dell’America centrale e meridionale, alcuni Paesi dell’Asia orientale e il Benin. La Figura 4 mostra la grande fluttuazione dei volumi di esportazione dei tre più importanti Paesi asiatici di destinazione e del Benin tra il 2012 e il 2022. Nei primi anni dell’ultimo decennio la Cina si è classificata al secondo posto tra i principali importatori, ma i focolai di Influenza Aviaria nel 2015 hanno ridotto drasticamente il volume delle importazioni, che è arrivato quasi a zero nel 2019. Dopo un anno di ripresa è diminuito di nuovo, riuscendo comunque a non crollare nel 2022. Nel primo trimestre del 2023 la Cina non importava più carne di tacchino
Tabella 2 – Contributo dei principali dieci Paesi di destinazione delle esportazioni americane di carne di tacchino nel 2014, 2015 e 2022; dati in migliaia di tonnellate (fonte: USDA, FAS). 2014
* il totale non aumenta per l’arrotondamento
29 - gennaio 2024MARKETING
2022 Paese Export Contributo (%) Paese Export Contributo (%) Paese Export Contributo (%) Messico Cina Canada Benin Filippine Giappone Hong Kong Panama Rep. Dom. Colombia 226.517 25.752 8.815 6.521 6.403 5.976 5.941 4.681 4.347 4.204 64,5 7,3 2,5 1,9 1,8 1,7 1,7 1,3 1,2 1,2 Messico Hong Kong Canada Giappone Panama Benin Rep. Dom. Gabon Giamaica Filippine 153.188 9.486 7.663 7.113 4.999 4.581 4.246 3.434 3.333 3.052 63,8 4,0 3,2 3,0 2,1 1,9 1,8 1,4 1,4 1,3 Messico Canada Benin Cina Guatemala Giamaica Panama Rep. Dom. El Salvador Costa Rica 129.718 6.444 4.062 3.981 3.286 3.126 2.898 2.820 2.456 2.446 70,2 3,5 2,2 2,2 1,8 1,7 1,6 1,5 1,3 1,3 10 Paesi 299.157 85,1 10 Paesi 201.095 *83,8 10 Paesi 161.237 87,2 Totale 251.404 100,0 Totale 239.930 100,0 Totale 184.837 100,0
2015
e FAS).
20122013201420152016201720182019202020212022
Kong
dagli Stati Uniti: in questa decisione, accanto ai focolai di Influenza Aviaria, possono aver giocato un ruolo anche le crescenti tensioni politiche. In alcuni anni (2016-2019) Hong Kong ha parzialmente compensato le importazioni in calo della Cina, ma dal 2020 in poi le importazioni sono diminuite notevolmente e hanno rivestito un’importanza minore per l’industria del tacchino americana.
L’andamento delle importazioni giapponesi è degno di nota: i focolai di Aviaria nel 2015 non hanno determinato un forte calo, bensì un aumento del volume delle importazioni nel 2016 e nel 2017. Negli anni successivi, tuttavia, il volume è sceso costantemente ed è stato inferiore di oltre il 90% nel 2022 rispetto al 2017. Nel primo trimestre del 2023 il Giappone ha importato solo circa
170 tonnellate dagli Stati Uniti, il che indica volumi di importazioni ancora bassi.
Le importazioni del Benin hanno subito notevoli fluttuazioni nel decennio in esame. I focolai di Influenza Aviaria hanno ovviamente avuto un impatto sul loro volume, diminuito notevolmente nel 2020 e nel 2022.
Poiché il Paese sta esportando grandi quantità delle importazioni verso altri Paesi africani, le decisioni di questi ultimi possono aver svolto un ruolo decisivo nel comportamento di importazione del Benin.
Sintesi e prospettive
I massicci focolai di Influenza Aviaria nel 2015 e nel 2022 hanno avuto effetti di vasta portata sulle esportazioni di carne avicola degli Stati Uniti.
La produzione di carne di pollo è stata meno colpita di quella di tacchino, soprattutto per i diversi momenti e i diversi luoghi in cui si sono verificati i focolai. Poiché l’allevamento di broiler è concentrato nel Sud-est e negli Stati del Medio Atlantico, i focolai hanno avuto un impatto minore sulla produzione della carne di pollo.
La massiccia riduzione del volume delle esportazioni nel 2015 è stata principalmente dovuta al divieto delle importazioni, stabilito in 30 Paesi. Ci sono voluti diversi anni per tornare al volume originario, poiché diversi Paesi hanno prolungato il divieto nel 2016 e anche nel 2017. La forte concorrenza del Brasile, della Turchia e di alcuni membri dell’UE consentirà solo un piccolo aumento delle esportazioni rispetto al volume del 2022.
30 - marketingMARKETING
[1.000 t] 0 13 25 38 50
Benin Cina Giappone Hong
Figura 4 – Sviluppo delle esportazioni di carne di tacchino dagli USA verso alcuni Paesi selezionati tra il 2012 e il 2022 (design: A.S. Kauer sulla base di dati USDA e FAS).
14,9% 1,2% 1,2% 1,3% 1,7% 1,8% 2,5% 7,3% 64,5% Messico Cina Canada Benin Filippine Giappone Hong Kong Panama Rep. Dom. Colombia Altri Totale: 351.404 t 2014 1,7% 1,9% 15,1% 1,2% 1,2% 1,4% 1,5% 1,8% 1,9% 2,4% 2,4% 3,0% 68,1% Messico Benin Canada Cina Rep. Dom. Guatemala Haiti Jamaica Panama Perù Altri Totale: 248.369 t 2021 16,1% 1,3% 1,4% 1,4% 1,8% 1,9% 2,1% 3,0% 3,2% 4,0% 63,8% Messico Hong Kong Canada Giappone Panama Benin Rep. Dom. Gabon Jamaica Filippine Altri Totale: 201.065 t 2015 12,8% 1,2% 1,3% 1,5% 1,6% 1,7% 1,8% 2,2% 2,2% 3,5% 70,2% Messico Canada Benin Cina Guatemala Jamaica Panama Rep. Dom. El Salvador Costa Rica Altri Totale: 184.837 t 2022
Figura 3 – Contributo dei principali dieci Paesi di destinazione delle esportazioni americane di carne di tacchino nel 2021 e nel 2022 considerati per volume (design: A.S. Kauer sulla base di dati USDA
Al contrario, le tempistiche e i modelli regionali dei focolai di Influenza Aviaria verificatisi negli allevamenti di tacchini nel 2015 e nel 2022 hanno avuto un impatto drastico sulle esportazioni. Il forte calo del 2015 è stato anche dovuto principalmente ai divieti di importazione, ma comunque negli anni successivi non è stato possibile raggiungere nuovamente il precedente volume di 350.000 tonnellate.
Il Servizio di ricerca economica dell’USDA prevede che le esportazioni di carne di tacchino persisteranno al livello del 2022 (piuttosto basso, con meno di 200.000 tonnellate) fino al 2024 e forse anche più a lungo. Diversi Stati membri dell’UE e il Brasile sono stati in grado di stabilizzare la loro posizione nel commercio globale di carne di tacchino e rappresentano dunque una grande sfida per l’industria della carne di tacchino statunitense.
Bibliografia e approfondimenti
FAO database: https://www.fao.org/faostat/en.
USDA, ERS: Livestock, Dairy, and Poultry Outlook: May 2023. https://www.ers.usda.gov/publications/pubdetails/?pubid=106570.
USDA, FAS: Brazil: Poultry and Products, Semi-Annual. GAIN Report BR2023-0005. https://www.fas.usda.gov/ data/brazil-poultry-and-products-semi-annual-7.
USDA, FAS: China: Poultry and Products, Semi-Annual. GAIN Report CH2023-0020. https://www.fas.usda.gov/ data/china-poultry-and-products-semi-annual-8.
USDA, FAS: Russia: Poultry and Products Annual. GAIN Report RS2020-0042. https://www.fas.usda.gov/data/ russia-poultry-and-products-annual-4.
USDA, NASS: Poultry production and Value. 2022 Summary. https://usda.library.cornell.edu/usda-esmis/files/ m039k491c/wm119387d/7p88dx55s/plva0423.txt.
Windhorst, H.-W.: Economic impacts of the AI-outbreaks in the USA in 2015. A final evaluation of the epizootic disaster. In: Zootecnica International 38 (2016), no. 7, p. 34-39.
Windhorst, H.-W.: Brazil and USA: Ongoing competition on the global chicken meat market. In: Zootecnica International 41 (2019), no. 6, p. 16-19.
Windhorst, H.-W.: Two waves, different routes and changing dynamics. The Avian Influenza outbreaks in the USA in 2022. In: Poultry World 39 (2023), no. 2, p. 8-11.

PROGETTUALITA’ • PROFESSIONALITA’ • AFFIDABILITA’ DA OLTRE 50 ANNI



I sistemi VDL Jansen sono noti per la loro qualità e affidabilità. Vengono proposte varie soluzioni, tra cui sistemi a voliera per ovaiole commerciali e svezzamento pollastre, nidi per ovaiole commerciali e riproduttori.




31 - gennaio 2024MARKETING

Indagine sull’impatto di un composto di tre ceppi di probiotici sulle prestazioni dell’asse intestinoencefalo
I.C.L. Almeida Paz1, J.C. Bodin2, P. Doyle3 e C. Culley3
1 Universidade Estadual Paulista, Julio De Mesquita Filho, Brazil
2 Chr. Hansen Animal & Plant Health and Nutrition, APAC Singapore
3 Nutriment Health Pty Ltd, Australia
La salute intestinale degli avicoli deve essere considerata, tra gli altri fattori, per raggiungere il livello massimo di assorbimento dei nutrienti e per far sì che il loro impiego nell’organismo si sviluppi in maniera adeguata; tutto ciò assicura la produttività dell’allevamento avicolo. Nondimeno, con la riduzione o il divieto su scala mondiale nell’utilizzo di antimicrobici per migliorare le prestazioni animali, la ricerca di prodotti che siano in grado di modulare il microbiota intestinale degli avicoli si è intensificata.
32 - nutrizionisticaNUTRIZIONISTICA
Introduzione
Gli enzimi, gli acidi organici, i prebiotici, i simbiotici e i probiotici sono tra gli additivi che migliorano le prestazioni agendo sul microbiota intestinale. In avicoltura i vari batteri Lactobacillus, Bacillus, Bifidobacterium ed Enterococcus sono comunemente usati come probiotici per supportare la salute intestinale e le performance in generale. Una preoccupazione sempre presente nei sistemi intensivi riguarda il comportamento e il benessere animale. Nella salute umana lo studio dell’asse encefalo-intestino-microbiota ha segnato grossi sviluppi negli scorsi anni come indicatore atto al riconoscimento delle interazioni tra i ceppi dei probiotici e le funzioni cognitive. Quindi anche per il settore avicolo si sono cominciati a valutare i probiotici per determinare i potenziali benefici che si avrebbero su entrambi gli indici di prestazione e sul benessere del broiler. I parametri di benessere come LTL, test d’approssimazione e le concentrazioni plasmatiche di serotonina sono stati descritti come rilevanti per il comportamento dei soggetti studiati e come indicatori di benessere. La serotonina (5-idrossitriptamina; 5-HT) è conosciuta come un neurotrasmettitore critico per lo sviluppo delle funzioni del sistema nervoso centrale e come ottimo indicatore di benessere animale.
Materiali e metodi
Sono stati assegnati 1600 broiler maschi (Aviagen AP95) in maniera randomizzata a uno dei quattro gruppi di trattamento (50 soggetti per replica, 8 repliche totali). Sono stati applicati quattro trattamenti: HAL (Halquinol a 75 mg/kg nel mangime), NC (gruppo di controllo negativo senza AGP, probiotici o miscele di oli essenziali o acidi organici), PRO (mix di ceppi di probiotici a 500 g/T di mangime), costituiti da B.Subtilis (DSM 32325), B.Subtilis (DSM 32324) e B.amyloliquefaciens (DSM 25840) e OA&EO (un composto di acido benzoico e timolo, eugenolo e piperina a 300 g/T di mangime). Lo stesso profilo nutrizionale è stato utilizzato per i trattamenti nelle diete durante le diverse fasi del ciclo. I broiler sono stati alimentati dal giorno 0 al giorno 42. Il volume di mangime ingerito, il peso corporeo, l’indice di conversione e la mortalità (%) sono stati misurati e raccolti su base settimanale. A 42 giorni d’età gli animali sono stati sottoposti a due test di benessere utilizzando un test LTL e un test d’approssimazione. Per il test LTL, un conteni-
“Anche per il settore avicolo si sono cominciati a valutare i probiotici per determinare i potenziali benefici che si avrebbero su entrambi gli indici
di prestazione e sul benessere del broiler”
tore in plastica di misura 75x50x20 cm è stato riempito con 3 cm d’acqua a temperatura ambiente, dove sono stati introdotti ogni volta 6 soggetti. È stato utilizzato un cronometro digitale per registrare il tempo che il soggetto impiegava per sdraiarsi. Il test è stato interrotto nel caso l’animale si trovasse ancora in postura eretta dopo 370 s. Per il test d’approssimazione, un operatore entrava nel recinto e, dopo 3 minuti, allungava il suo braccio contando quanti animali poteva raggiungere e toccare. A 42 giorni d’età è stato misurato il punteggio posturale utilizzando un sistema a tre categorie (0: nessun segno obiettivo; 1: segni presenti; 2: segni gravi). Le concentrazioni plasmatiche di serotonina sono state misurate a 40 giorni d’età utilizzando un kit Elisa serotonina/idrossitriptamina 5-HT. I campioni sono stati raccolti dall’8% dei broiler per ogni trattamento. I dati sono stati analizzati utilizzando un programma SAS 9.2, ANOVA e il test di Tukey (P<0.05) per i dati parametrici e il Chi-Square o il test di Fisher (P<0.05) per i dati non-parametrici.
Risultati e discussione
Come riassunto nella Tabella 1, la somministrazione giornaliera con il mangime di PRO e OA&EO ha avuto come risultati significativi miglioramenti nel peso corporeo finale ed EPEF corretto alla mortalità (P<0.05) rispetto ai gruppi trattati con NC e HAL.
- gennaio 2024 - 33 NUTRIZIONISTICA
SEMPRE AGGIORNATI SULLE ULTIME NOVITA’ del settore avicolo con
Tabella 1 – Peso corporeo (g), indice di conversione (FCR), mortalità (%) e risultati EPEF dei diversi gruppi di trattamento a 42 giorni d’età.

Zootecnica International offre un’ampia panoramica sull’avicoltura con notizie, approfondimenti, interviste, tendenze di mercato e articoli tecnici e scientifici.
Edita in tre lingue, italiano, russo e inglese, è diretta a tutti gli operatori della filiera avicola: allevatori, produttori di uova, case di selezione, incubatoi, mangimifici, aziende di lavorazione e trasformazione di carne avicola e di uova.
zootecnica.it
a,b,c I termini all’interno della colonna che non condividono un suffisso comune sono significativamente diversi a P<0.05.
L’indice di conversione (FCR) è risultato significativamente inferiore nei soggetti a cui è stato somministrato il trattamento con PRO rispetto a quelli di qualsiasi altro tipo. Il trattamento non ha avuto un impatto significativo sul tasso di mortalità (%). La tendenza a sdraiarsi per i punteggi posturali tra lo 0 e 1, rappresentanti il 90% dei soggetti, è mostrato nella Figura 1. Il gruppo alimentato con PRO ha mostrato un tempo di stazionamento in postura eretta significativamente più elevato nel test LTL rispetto a quei soggetti alimentati con NC, HAL e OA&EO, suggerendo la maggiore resilienza allo stress nonché un miglior stato sanitario a livello di arti inferiori.

del tempo intercorso prima di sdraiarsi (LTL), misurati in minuti e secondi, del gruppo trattamento per i broiler con un punteggio di indice posturale di 0 e 1.
La Figura 2 mostra come, nella valutazione del test d’approssimazione eseguito su soggetti con punteggio di postura 0, dopo 3 minuti nel recinto, la percentuale dei soggetti che hanno toccato l’operatore è stata significativamente più elevata per i broiler alimentati con PRO rispetto agli altri gruppi a cui è stato somministrato HAL, NC e OA&EO: tali gruppi hanno mostrato percentuali più basse di soggetti toccati dall’operatore. In parallelo al-
34 - nutrizionisticaNUTRIZIONISTICA
Trattamento Peso corporeo (g) FCR Mortalit à (%) EPEF HAL 3103 c 1.52 a 1.71 478 c NC 3086 c 1.51 a 1.79 478 c PRO 3209 a 1.48 b 2.57 503 a OA & EO 3168 b 1.51 a 2.00 489 b Valori di P 0.001 0.001 0.522 0.023
0.00 0.50 1.00 1.50 2.00 2.50 3.00 3.50 4.00 4.50 Gait score 0 Gait score 1 HAL NC PRO OA & EO Minutes 3.10b 2.20 4.29a 3.28b 2.17b 1.20c 2.59a 1.48c P = 0.033 CV (Coefficient of Variation) = 3.43% P = 0.011 CV = 4.25%
Figura 1 – Risultati del test
l’LTL e ai test di approssimazione, sono stati misurati i livelli plasmatici di serotonina a 40 giorni d’età e i risultati sono presentati nella Tabella 2.














trattamento.
Tabella 2 – Misurazioni dei livelli di serotonina plasmatica (5-HT) nei broiler per ogni gruppo trattamento di 40 giorni d’età.
Trattamento Serotonina (5-HT) µ g/ml







a,b,c I termini all’interno della colonna che non condividono un suffisso comune sono significativamente diversi a P<0.05.
I soggetti che hanno ricevuto un mix di tre ceppi di probiotici (PRO) hanno mostrato livelli plasmatici di serotonina significativamente più elevati (P=0,001) rispetto ai gruppi HAL, NC e OA&EO. Oltre a questo, il benessere degli animali è aumentato in maniera significativa quando è stata somministrata la dieta integrata con PRO: punteggi migliori nell’LTL e i risultati dei test di approssimazione indicano la tendenza di questi animali a essere più tranquilli e resilienti allo stress. Elevati livelli plasmatici di serotonina (µg/ml) a 40 giorni d’età dei broiler alimentati con il trattamento PRO supportano l’impatto positivo che quest’ultimo ha sulle prestazioni e sul benessere dei broiler.
La bibliografia è disponibile su richiesta Dagli Atti dell’Australian Poultry Science Symposium 2023
- gennaio 2024 - 35 NUTRIZIONISTICA
0 2 4 6 8 10 12 14 Gait score 0 HAL NC PRO OA & EO % of birds touched/assessor af t er 3 mi n 11.25b 8.25c 12.67a 10.92b P = 0.001
Figura 2 – Risultati del test di approssimazione espressi in percentuale di animali toccati dall’operatore dopo 3 minuti nel recinto (per broiler con un punteggio d’indice posturale di 0) per ogni gruppo
HAL 91 c NC 100 c PRO 402 a OA & EO 316 b Valore di P(%) 0.001 CV (%) 1.86
Isabel Gimeno
North Carolina State University

Aggiornamento sulla malattia di Marek: situazione attuale e prospettive future
In questo articolo, presentato alla XXII World Veterinary Poultry Association Conference che si è tenuta a Verona lo scorso settembre, l’autrice parla del virus della malattia di Marek, valutando le due sindromi che hanno maggiore rilevanza economica nel campo: l’immunosoppressione indotta da MDV (MDV-IS) e i tumori indotti da MDV (MD).
Evoluzione della MD ed MDV
La malattia di Marek (MD) è stata descritta per la prima volta nel 1907 da Joseph Marek. Inizialmente è stata presentata come una polineurite che colpiva solo i soggetti anziani e
36 - veterinariaVETERINARIA
senza importanza economica. Solo verso la fine degli anni ’50 è stata identificata come un importante rischio per l’industria avicola. La MD non era più solamente una malattia infiammatoria, ma aveva assunto anche forme neoplastiche, colpiva soggetti molto giovani e la mortalità era molto alta. Da allora il suo controllo è diventato fondamentale per lo sviluppo dell’avicoltura. I primi vaccini furono preparati tra la fine degli anni ’60 e gli inizi degli anni ’70 e furono non solo un successo per la produzione, ma anche per la ricerca: si trattava infatti dei primi vaccini efficaci verso i tumori. Tali vaccini però controllavano solo lo sviluppo della malattia, non la sua infezione o trasmissione, e questa mancanza di “sterilizzazione immunitaria” costituisce proprio uno dei principali fattori di aumento di virulenza del virus della malattia di Marek (MDV).
L’MDV è un alfa-herpesvirus del genere Mardivirus che include tre specie: Gallid alphaherpesvirus 2 (precedentemente noto come sierotipo 1 MDV o MDV-1), Gallid alphaherpesvirus 3 (noto come 2 MDV o MDV-2) e Meleagrid herpesvirus (noto come sierotipo 3 or HVT ).
MDV-1 include tutti i ceppi oncogenici MDV e le loro forme attenuate. Ne esistono vari patotipi, classificati sulla base della loro capacità di superare le difese costituite dalla vaccinazione. Avremo quindi i ceppi medi (m), virulenti (v), molto virulenti (vv) e molto virulenti più (vv+). Il passaggio da m a v fu osservato verso la fine degli anni ’50; quello da v a vv verso la fine degli anni ’80 in seguito a episodi in gruppi vaccinati con HVT, e infine il passaggio a vv+ causò focolai in gruppi vaccinati HVT+SB-1 e CVI988 verso la fine degli anni ’90.
Oltre a provocare tumori in polli vaccinati, MDV-1 vv+ ha sviluppato altre forme capaci di causare diverse sindromi, tra cui paralisi acuta transitoria, sindromi linfodegenerative, panoftalmite, aterosclerosi e grave immunosoppressione. In questo articolo vedremo le due forme che hanno maggiore rilevanza economica in campo: la immunosoppressione (MDV-IS) e i tumori (MD).
MDV-IS
Si tratta di un sindrome assai complessa, che può venire suddivisa in 3 fasi differenti, che possono non essere correlate tra loro, ma in certi casi invece si sommano. Si tratta delle infezioni citolitiche precoci, che avvengono a carico degli organi linfoidi già pochi giorni dopo l’infe -
“La diagnosi di MD richiede un approccio a stadi multipli. A livello di allevamento, informazioni epidemiologiche (età, stato vaccinale, etc.), sintomi clinici e lesioni, possono suggerire, e a volte confermare, la diagnosi. L’istopatologia è il primo passo per confermare che si tratta di tumori e linfomi; se essa non permette diagnosi, o se non è possibile eseguirla, occorrono altri test, come PCR o immunoistochimica”
zione (MDV-IS precoce), della riattivazione virale dopo un periodo di latenza (MDV-IS/R tardiva) e dello sviluppo dei tumori (MDV-IS/T finale). In ognuna di queste fasi il virus riesce a dare immunosoppressione tramite diversi meccanismi.
MDV-IS precoce
Dopo che il pulcino viene infettato per via respiratoria, il virus viene trasportato verso gli organi linfatici, probabilmente da cellule dendritiche e macrofagi. Nei pulcini sprovvisti di anticorpi materni il virus si trova nella borsa, nella milza e nel timo già a 3 giorni e il picco della sua replicazione avviene tra i 4-6 giorni. Dopo il virus entra in un periodo di latenza e diventa difficile da rilevare. Nel corso della sua replicazione massiva negli organi linfatici, avviene una distruzione dei linfociti per apoptosi e quindi l’organo linfatico si atrofizza. Inoltre, i linfociti che sopravvivono sono alterati e non riescono a proliferare per la presenza di macrofagi soppressori: pertanto si crea una grave immunosoppressione umorale e cellulare. Gli anticorpi materni proteggono in qualche modo il danno iniziale agli organi linfoidi, ma tale effetto è parziale, quando il virus infettante è vv, e soprattutto quando è vv+. La MD precoce è inoltre difficile da diagnosticare in campo, perché l’atrofia degli organi linfoidi può essere causata anche da altri agenti (IBD, CAA, micotossine, etc.). Comunque MDV dovrebbe essere sempre considerata in sede di diagnosi differenziale, specialmente in gruppi non vaccinati.
- gennaio 2024 - 37 VETERINARIA
MDV-IS/R tardiva
Si verifica nel corso della seconda infezione citolitica (3-4 settimane) quando il virus si riattiva dal periodo di latenza. Oltre alla distruzione delle cellule, il virus causa una forte disregolazione delle risposte immunitarie. Questa è la fase più difficile da studiare, perché non è correlata all’atrofia degli organi linfoidi e nemmeno ai tumori. In un modello di studio in laboratorio, che sfrutta la capacità di MDV di mettere a rischio la protezione conferita dai vaccini verso la laringotracheite (ILT), è stato possibile dimostrare che vv+, ma non altri patotipi, è stata capace di bloccare i vaccini CEO nella protezione verso ILT. Inoltre nessuno dei vaccini tradizionali (CVI988; HVT+CVI988; HVT+SB-1 ed SB1 da solo) somministrati in ovo oppure alla schiusa, come pure in protocolli di rivaccinazione, sono stati in grado di proteggere completamente verso la MDV-IS/R causata da ceppi vv+, anche se alcuni protocolli vaccinali proteggevano abbastanza bene verso le forme tumorali. Poiché non disponiamo di metodi di diagnosi o controllo, questa rappresenta una delle peggiori forme di MD al momento.
MDV-IS/T finale
Si verifica una volta che i tumori si sono sviluppati. Poiché essi richiedono una riattivazione virale, l’infezione citolitica secondaria (e la MDV-IS tardiva) possono oltrepassare lo sviluppo tumorale. Le cellule CD4+ T sono quelle più modificate del virus. I tumori possono causare immunosoppressione tramite diversi meccanismi. Le cellule MDV trasformate possono adottare il fenotipo delle cellule T regolatorie e produrre
fattori di crescita della citochina beta (TGF-), che può inibire la proliferazione di cellule T e interferire sulla loro funzione. Le cellule trasformate da MDV sopprimono anche la linfoproliferazione e riducono la regolazione di CD28, che è una importante molecola citostimolatrice nell’attivazione delle cellule T. Inoltre, MHC-I viene soppressa nelle cellule tumorali MD a seguito della riattivazione virale e PD-L1 e PD-L2 vengono espressi nei linfomi MD indotti. La rilevazione dei tumori indotti da MDV è sufficiente per confermare la MDV-IS tardiva. Nello stesso modo la protezione nei confronti del tumori indotti garantirà la protezione contro la MDV-IS.
Conseguenze in campo
La capacità di immunosoppressione di MDV e il modo in cui viene controllata dipendono notevolmente dal patotipo e dall’età dei polli alla fine del ciclo. Negli allevamenti di broiler infettati da MDV, anche se non sono vaccinati, potrebbe non verificarsi mai MDV-IS. Se c’è una infezione da ceppi vv+ ma i pulcini sono ben vaccinati verso i tumori indotti da MDV, MDV-IS non si verifica. Però, anche nel caso siano ben protetti nei riguardi delle forme tumorali, soffrono comunque di MDV-IS tardiva nel caso l’infezione sia da vv+. I diversi scenari sono descritti nella Tabella 1
Studi futuri
Sarà fondamentale capire il meccanismo tramite il quale vv+MDV può indurre immunosoppressione nel pollo, che altrimenti sarebbe protetto nei confronti dei tumori indotti da MDV. La valutazione di come rMd5Δmeq protegge nei confronti di MDV-IS/R potrebbe essere utile nello sviluppare metodiche di diagnosi e controllo, al momento decisamente necessarie e urgenti.
Tumori indotti dal virus Marek
Diagnosi
Nella diagnosi differenziale dei tumori da MD bisogna valutare diverse malattie, sia neoplastiche che non. Esiste una buona bibliografia che indica come indirizzare la diagnosi negli avicoli. In questo articolo ci concentreremo principalmente su quelle malattie che possono essere confuse con MD e che sono riassunte in Figura 1.
La diagnosi di MD richiede un approccio a stadi multipli. A livello di allevamento, informazioni epidemiologiche (età, stato vaccinale, etc.), sintomi clinici e lesioni, possono suggerire, e a volte confermare, la diagnosi. L’istopatologia è il primo passo per confermare che si tratta di tumori e linfomi; se essa non permette diagnosi, o se non è possibile
Tabella 1 – EffettI del patotipo MDV su MD-IS e metodi di controllo.
Infezione MDV-IS MDV-IS/R MDV-IS/T
v protezione da anticorpi materni non esiste protezione vaccinale
vv protezione vaccinale non esiste protezione vaccinale
vv+ protezione vaccinale esiste - i protocolli vaccinali tradizionali non proteggono protezione vaccinale
38 - veterinaria -
VETERINARIA
MENO SPRECHI = PIÙ RISULTATI

RISPARMIA ENERGIA1
PIÙ PERFORMANCE2
I β-mannani incrementano i costi di alimentazione sprecando energia.
La risposta immunitaria indotta dagli alimenti (FIIR), scatenata dai β-mannani, riduce l’energia disponibile per la crescita e influenza negativamente la salute intestinale degli animali – sprecando fino al 3% dell’energia fornita con il mangime1.
HemicellTM HT degrada I β-mannani PRIMA che possano scatenare la FIIR.
HemicellTM HT risparmia energia ed elimina i costi dei β-mannani
1.
PIÙ INTEGRITÀ INTESTINALE3,4
Daskiran M, et al. (2004) An Evaluation of Endo-β-D-mannanase Hemicell) Effects on Broiler Performance and Energy Use in Diets Varying in β-mannan Content. Poultry Sci. 83: 662-668. 2. Hemicell EMEA field experience. Data on file. 3. Poulsen K. (2021) Effects of Hemicell on Intestinal Health in broilers analyzed in 44 Experiences. Data on file. 4. David Zhu. (2021) Meta-analysis of HTSi for 24 Hemicell Trials in APAC. Data on file. Hemicell, Elanco e la barra diagonale sono marchi registrati di Elanco o sue affiliate. © 2023 Elanco. PM-IT-23-0119 Elanco Italia S.p.A. – Via dei Colatori 12, 50019 Sesto Fiorentino (FI)
eseguirla, occorrono altri test, come PCR o immunoistochimica.
Un concetto critico nella diagnosi di MD è che la presenza di MDV oncogenico non significa MD. Poiché infatti i vaccini non proteggono verso l’infezione, la maggior parte (se non tutti) degli avicoli commerciali è esposta a MDV oncogenico in determinati momenti. Diventa quindi critico differenziare tra infezioni latenti e sviluppo dei tumori.
Controllo del focolaio
Investigare le cause di un focolaio di MD è fondamentale per averne il controllo appropriato.
Nella Figura 2 è evidenziato un diagramma di flusso con gli step raccomandati. Una volta che la diagnosi di MD è confermata, è importante eseguire un audit in incubatoio, per accertarsi che i vaccini siano somministrati correttamente: essi sono infatti estremamente la-
Focolaio da MD
Audit in incubatoio
Esito favorevole
Replicazione virale nei pulcini (PCR - polpa penne a 7-10 gg)
esito negativo
basso titolo vaccinale
Esito sfavorevole interazione con altri vaccini somministrati contemporaneamente
Rendere più efficaci i protocolli vaccinali in incubatoio
esito positivo
infezione precoce con alta carica di MDV oncogenici a 7 gg (PCR) ceppi virali più virulenti coinfezione di altre malattie (es. CIAV)
Valutare i protocolli vaccinali
bili e la maggior parte delle rotture vaccinali deriva proprio da problemi di conservazione, manipolazione o somministrazione degli stessi. È importante ricordare che i vaccini MD sono sospensioni instabili di cellule e che la maggioranza delle cellule in una provetta è non infettata. Perderne anche soltanto una piccola percentuale potrebbe pertanto significare una riduzione del titolo.
La valutazione della replicazione in vivo del vaccino a 7-10 giorni di vita può confermare se il vaccino sia o meno stato somministrato correttamente. La replicazione vaccinale viene valutata sia nella milza che nella polpa del follicolo delle penne o con qPCR. Una buona percentuale dei polli con livelli rilevabili di vaccino dipende dal protocollo vaccinale utilizzato (vaccino o vaccini usati ed età della vaccinazione), ma non fornirà informazioni circa lo stato vaccinale, anche se potrà fornire una buona stima di come i vaccini sono stati manipolati e somministrati.
Il vaccino MD richiede 5-7 giorni per produrre il livello ottimale di protezione. Si tenga conto che in un allevamento commerciale le infezioni spesso avvengono entro i primi giorni di vita. Per escludere qualsiasi infezione precoce, è possibile controllare la carica del DNA dei virus oncogenici, sia nella milza che nella polpa follicolare delle penne raccolte a 7 giorni. I polli positivi per MDV oncogenico sono una chiara evidenza di infezione precoce e indicano fortemente rotture nei protocolli di biosicurezza come causa primaria.
Monitorare il DNA di MDV oncogenico a tarda età (dai 21 giorni in poi) può essere utile per determinare se il programma vaccinale protegge nei confronti delle infezioni esistenti. È
40 - veterinariaVETERINARIA
<14 weeks >14 weeks Nerve enlargement MD Peripheral neuropathy Real time PCR Histopathology Real time PCR Histopathology Real time PCR Histopathology Immunohistochemistry Real time PCR Histopathology Immunohistochemistry Acutely transforming retroviruses Peripheral neuropathy Neuritis (REV) MD MD MD MD REV REV Spontaneus Spontaneus REV ALV ALV MD MD Visceral tumors Nerve enlargement &Visceral tumors Nerve enlargementVisceral tumors bursal tumors Nerve enlargement &Visceral tumors
Figura 1 – Diagramma di flusso per la diagnosi differenziale delle malattie tumorali.
Figura 2 – Analisi di un focolaio da MD
stato dimostrato che, già a 21 giorni, è possibile dividere i polli in 3 categorie (negativi, in latenza o con tumori) sulla base del DNA di MDV oncogenico presente sia nella polpa delle piume che nel sangue. La percentuale di pulcini che ricade nella categoria dei tumori tramite qPCR a 3 settimane è correlata (r= P<0,05) con lo sviluppo di tumori verso le 8 settimane di vita.
Controllo
Il controllo della MD si basa su resistenza genetica, buona biosicurezza, e vaccinazione adeguata. I vaccini sono più efficienti nelle linee di polli resistenti. Inoltre, indipendentemente dalla bontà del vaccino, esso non conferisce protezione all’infezione se questa avviene troppo precocemente; quindi, anche se la vaccinazione è la pietra miliare del controllo della MD, resistenza genetica e biosicurezza non vanno ignorate. Esistono dei validi studi su questi argomenti. Vediamo i tipi di vaccino in uso e come migliorare la protezione che essi inducono.
Tipi di vaccino
Esistono diverse classificazioni di vaccini MD. Possono essere suddivisi in vaccini su cellula (congelati o in azoto liquido) o senza (liofilizzati), oppure, se ci si basa sul sierotipo in MDV-1,MDV-2 e HVT; infine in convenzionali o ricombinanti. In questo articolo usiamo quest’ultima classificazione.
Vaccini convenzionali. In questa categoria troviamo i ceppi MDV-1 attenuati (CVI988), quelli naturalmente non oncogenici MDV-2 (come SB-1 e 301B) e naturalmente gli HVT non oncogenici. Tutti questi possono essere cellulo-associati ma solo HVT può essere senza cellule, anche se la protezione è inferiore rispetto ad HVT su cellule. La somministrazione di HVT ed MDV2 in contemporanea fornisce una maggior protezione, detta sinergismo protettivo. Tale sinergismo non avviene tra CVI988 e HVT, nonostante la combinazione di questi due ceppi sia pratica comune nell’industria avicola. In genere, i broiler sono vaccinati con HVT, mentre i soggetti a lunga vita (riproduttori e ovaiole) lo sono con MDV-2 e HVT, con CVI988, oppure con HVT e CV1988. L’efficacia dei vaccini MDV dipende notevolmente dall’aplotipo B e quindi la combinazione di vari vaccini potrebbe dare luogo a una migliore protezione del gruppo.
Vaccini ricombinanti. Lo sviluppo di vaccini ricombinanti MD è partito nei primi anni anni ’90, ma è negli ulti-
mi 15 anni che sono diventati disponibili in commercio e ampiamente usati nell’industria avicola. Tutti i vaccini ricombinanti in uso sono cellulo-associati. Esistono due tipi di vaccini ricombinanti commerciali verso MD: vaccini vettori, che usano HVT come base (rHVT) e vaccini chimera, che sono ceppi di MDV con l’inserzione di una lunga ripetizione terminale (LTR) del virus della reticoloendoteliosi (REV). I pro e contro di questi vaccini sono riassunti in Tabella 2
Tabella 2 – Uso di vaccini rHVT: pro e contro.
PRO CONTRO
• Interazione con anticorpi materni bassa o nulla
• Somministrazione in ovo sicura
• Utilizzo mondiale (broiler)
• Trasmissione orizzontale bassa o nulla
• Immunità di lunga durata
• L’espressione dipende dalla replicazione di HVT
- vaccino associato a cellule
- la replicazione di HVT è influenzata dalla dose, dalla modalità di vaccinazione e dalla combinazione con altri vaccini MD
• Può interagire con altri HVT
• Limitata protezione verso MD
• Si esprime solo in 1 o 2 inserzioni
Metodiche per migliorare la protezione vaccinale
Si possono usare diverse strategie per migliorare la protezione vaccinale: vaccinazione in ovo, rivaccinazione e uso di adiuvanti. La vaccinazione in ovo ha diversi vantaggi rispetto a quella eseguita a un giorno di vita: si tratta di una pratica completamente automatizzata, che riduce il lavoro e gli errori umani e che consente la somministrazione del vaccino già 3 giorni prima della schiusa, conferendo elevati livelli di protezione nei confronti delle infezioni precoci, aumentando in tal modo lo sviluppo del sistema immunitario.
- gennaio 2024 - 41 VETERINARIA
“La situazione ideale per impedire l’evoluzione di MDV è quella di trovare vaccini che blocchino l’infezione nel punto di ingresso o che ne fermino la trasmissione dall’epitelio dei follicoli delle penne. Un secondo approccio prevede il controllo della nuova sindrome associata a ceppi molto virulenti. Gli studi dimostrano che quando MDV diviene più virulento, è anche più immunosoppressivo”
Tabella 3 – Pro e contro dell’uso
di
vaccini REV LTR. PRO CONTRO
• Buona protezione verso i tumori in caso di infezione precoce da ceppi vv+MDV
• Possono fungere da vettori per vaccini bivalenti o ricombinanti
• Replicano molto bene nel pollo
Prospettive future
• Alcuni ceppi, se non tutti, possono dare atrofia della borsa e del timo nei soggetti privi di anticorpi materni
• Hanno una parte LTR di REV, importante per la diagnosi basata su PCR
• Il monitoraggio della vaccinazione sulle piume a 7 gg non funziona (organi linfoidi positivi a 5-6 gg di vita)
Poiché nessuno dei vaccini MD conferisce un’immunità sterilizzante, MDV continuerà ad evolvere facilmente. Due sono gli approcci che si potranno adottare per controllare i ceppi emergenti. La situazione ideale per impedire l’evoluzione di MDV è quella di trovare vaccini che blocchino l’infezione nel punto di ingresso o che ne fermino la trasmissione dall’epitelio dei follicoli delle penne. Sviluppare vaccini capaci di indurre un’immunità sterilizzante verso un herpesvirus è però piuttosto difficile, anche se una migliore conoscenza del meccanismo dell’infezione da MDV nei polmoni e nell’epitelio dei follicoli potrebbe tornare utile.
Anche la rivaccinazione può aumentare la protezione dei vaccini già precedentemente somministrati prima dell’infezione e il secondo vaccino risulta sempre più efficace del primo. Il protocollo di rivaccinazione ideale include la vaccinazione in ovo con HVT o la combinazione di HVT e altri vaccini MD, seguiti poi da vaccini bivalenti o CVI988. La somministrazione in ovo di HVT comporta una forte attivazione dell’immunità, sia innata che cellulomediata, alla schiusa,così il pulcino sviluppa maggiori risposte immunitarie verso il secondo vaccino.
L’uso di adiuvanti nei vaccini MD è stato studiato nel passato e viene ancora usato, ma non è da tutti condiviso. Recentemente, però, lo sviluppo di nuovi adiuvanti suggerisce che quelli a base TLR-3 e TLR-21 potrebbero aumentare la protezione verso MD.
Un secondo approccio prevede il controllo della nuova sindrome associata a ceppi molto virulenti. Gli studi dimostrano che quando MDV diviene più virulento, è anche più immunosoppressivo.
Oggi, abbiamo strumenti per la diagnosi e il controllo dei tumori indotti da MDV, ma mancano metodi di diagnosi e controllo di MDV-IS indotto da vv+MDV. Bisogna capire il meccanismo per cui vv+MDV riesce a dare immunosoppressione anche in un pollo ben vaccinato e protetto verso i tumori e valutare come rMd5eq protegga verso MDV-IS/R tardivo.
Ciò è fondamentale per stabilire i criteri di diagnosi e le strategie di controllo. Sulla base delle nostre informazioni attuali, bloccare o ridurre la riattivazione di MDV nei linfociti potrebbe essere dunque utile nel controllare non solamente i tumori, ma anche MDV-IS. Le nuove tecnologie per valutare la patogenesi di MDV, come pure lo sviluppo dei vaccini, saranno pertanto la base per il futuro controllo di MDV.
Bibliografia disponibile su richiesta
Dagli atti della XXII WVPA Conference 2023
42 - veterinariaVETERINARIA


Aviagen La scelta Giusta

Polli per ogni segmento di Mercato. Il portafoglio più ampio nel settore del Pollo da Carne. Impareggiabile diversità di linee genetiche per rispondere alle Vostre esigenze. Visita il sito Aviagen.com


Incubatrici
















leader in incubators & complete hatchery solutions
www.petersime.com World
Specialisti
per tutti i tipi di uova.
in starne, fagiani e struzzi. Via Bancora e Rimoldi 3 – 22070 Guanzate (COMO) 39-031.352.91.22 – 031.352.91.29 - Fax: 39-031.352.95.91
INCUBATORS SPECIALIST SINCE 1924
E-mail: victoria@victoria-srl.com
e
10.000 uova
Incubatrici automatiche
digitali da 18 to
di capacità
E-mail: fiem@fiem.it A.L.I. srl • via Salvador Allende, 75H 47043 Sant’Angelo di Gatteo (FC) Italia T: 0541 941673 • F: 0541 348781 • info@lohmann.it info@cobbvantress.com The Chicken Experts. Bábolna TETRA Kft. H-2943, Bábolna, Radnóti M. u. 16. tel.: +36 95 345 008 info @ babolnatetra.com www.babolnatetra.com AFFID A BILITÀ COMPE T ENZA T R ADIZIONE RIC E RCA QUALI TÀ aviagen.com ROSS 308 DELIVERS Ross Zootecnica Magazine Market Guide Ad - ENGLISH.indd2/10/201 1:34 PM aviagen.com Rowan Range Zootecnica Magazine Market Guide Ad Italian - ENGLISH.indd 1 6/5/19 11:05 AM Riproduttori Riproduttori e Incubatoi
Via G.Galilei 3 – 22070 Guanzate (COMO) - Fax: +39-031.899.163
www.agritech.it – e-mail: commerce@agritech.it

CARFED INTERNATIONAL LTD
Leader in pig & poultry equipment
THE MOST INNOVATIVE RANGE FOR POULTRY FEEDING
Via Roma 29, 24030 Medolago (BG) Italy - Phone +39 035 901240
Fax +39 035 902757 info@azainternational.it www.azainternational.it
Attrezzature
BELTS AND ROPES FOR AVICULTURAL US E
Manure removal belts an d Manure belt with holes for drying system s
Via Garibaldi, 54 – 26040 Scandolara Ravara (CR) Italy
Tel. (+39) 0375/95135 • Fax. (+39) 0375/95169 info@barbieri-belts.com • www.barbieri-belts.com
Via
Ground Floor, One George Yard, Londra EC3V 9DF, Regno unito Тel.: + 44. 20. 7660.0987- Email: carfed@carfed.co.uk








Tel.

TURNKEY PROJECTS
POULTRY INTEGRATED PROJECTS
POULTRY EQUIPMENT FOR BROILERS AND LAYERS AVIARY SYSTEMS
Officine Facco & C. S.p.A. Via Venezia, 30 - Marsango (PD) Italy
Tel. +39 049 9698111 - Fax +39 049 9630605 | www.facco.net - facco@facco.net spazio55x45-facco.indd 2 03/10/14 15:06
Corti Zootecnici Srl | Via Volta 4, Monvalle (VA) - Italy
www.cortizootecnici.it CODAF Poultry Equipment Manufacturers
+39 0332 799985 | info@cortizootecnici.com |
Cavour, 74/76 • 25010 Isorella (Brescia), ITALY Tel. +39 030 9958156 • Fax: +39
info@codaf.net • www.codaf.net IMPIANTI CHIAVI IN MANO Partner commerciale di: Viale dell’industria, 55 - 37042 Caldiero (VR) Tel.: 045982022 - www.cizo.it - info@cizo.it P OU LT RY E QU IP MEN T www.bigdutchman.it The No. 1 Sede Operativa: Via dell’Industria 9 46043 Castiglione delle Stiviere (MN) Tel: +39 0376 636215 – Fax: +39 0376 1379121 Sede: Piazza Oberdan, 3, 20129 Milano Magazzino: Via Basilicata, 10, 20098 San Giuliano Milanese Tel.: +39 02 9881140 - Fax: +39 02 98280274 Email: carfed@carfed.it - Web: www.carfed.it
UK:
030 9952810
Sede
Attrezzature

GmbH & Co. KG
Dassendaler Weg 13 • D-47665 Sonsbeck (Germany)
T: +49 (0) 2838 912-0 • F: +49 (0) 2838 2791 info@specht-tenelsen.de • www.specht-tenelsen.de
VALLI spa • via Cimatti, 2 • 47010 Galeata (FC)
T: +39 0543 975 311 • F: +39 0543 981 400 E: info@valli-italy.com • I: www.valli-italy.com


PRODUZIONI CHIAVI IN MANO
ATTREZZATURA AVI CUNICOLA
Sistemi di abbeveraggio per pulcini, polli da carne, galline ovaiole, pollastre, riproduttori, tacchini, conigli e suini
Conveyor per la centralizzazione della raccolta delle uova
Sistemi di raffrescamento a nebbia e a pannello
LUBING
via Marco Polo, (Z.I.) Campodarsego, Padova Italy tel. + fax + info@lubing.it www.lubingsystem.com
SISTEM SRL Italia lubingsystem.com







Housing equipment for breeders, layers and broilers.
Giacomo Pallavicini Area Sales Manager South Europe giacomo.pallavicini@vencomaticgroup.com +39 3478626334
www.vencomaticgroup.com
ZOOTECNICA.IT
1969
ATTREZZATURE E TECNOLOGIE AVANZATE per allevamenti zootecnici





Via E. Torricelli 13 - 37135 Verona, Italia
Tel. +39 045 503289 - tezza@tezza.it - www.tezza.it

2023
MODULA LA TRAMOGGETTA SPECIFICA PER TACCHINI
8 ~ 10 marzo
VIV ASIA
International trade show from feed to food for Asia
ROBUSTA E FACILE DA GESTIRE
IMPACT Exhibition Center
Bangkok, Tailandia
Per informazioni:
VNU Exhibitions Europe
Tel.: +31 (0) 30 295 2700
South East Asia
Leader in livestock feeding systems
Utilizzabile dal primo giorno senza pulcini nel piatto fino ai tacchini maschi pesanti e nervosi.
VNU Exhibitions Asia Pacific Co., Ltd.
88 The PARQ, 4th Fl., West Wing
Ratchadaphisek Rd., Khlong Toei, Bangkok 10110 Thailandia
Tel.: +662 111 6611
Lavaggio rapido e totale di tutte le parti della tramoggetta.
Email: viv@vnuasiapacific.com
Web: vivasia.nl
Montaggio e smontaggio dell’anello antispreco rapido, sicuro e senza l’utilizzo di attrezzi o viti.
11 ~ 13 aprile
PEAK 2023: Where North American Poultry Connects Minneapolis, Minnesota, Stati Uniti

3 ~ 5 maggio
Fieravicola
Centro Espositivo di Rimini
Rimini, Italia

Mrs Hande Çakıcı
Tel.: +90 212 216 4010
Fax: +90 212 216 3360
Email: hande@hkf-fairs.com
Web: www.vivturkey.com
21 ~ 24 giugno
23° European Symposium on Poultry Nutrition - ESPN 2023 Palacongressi Rimini
Rimini, Italia
VNU Exhibitions Europe
P.O.Box 8800
3503 RV Utrecht, Paesi Bassi
Tel.:
Email:
Web:
Abu Dhabi National Exhibitions Company (ADNEC)
Khaleej Al Arabi Street
P.O. Box 5546
Abu Dhabi, United Arab Emirates
Tel.:
Fax:

AGENDA
VOGLIO AZA!
QUALITY MADE IN ITALY www.azainternational.it
GUIDA INTERNET
ADM Animal Nutrition Italy S.r.l. it.suppor t@wisium.com www.admanimalnutrition.com
sAgritech commerce@agritech.it www.agritech.it
Albitalia infotecniche@albitalia.com www.albitalia.com
Albors info@albors.it www.albors.it
Ali Lohmann info@lohmann.it www.alilohmann.com
Arion Fasoli info@arionfasoli.com www.arionfasoli.com
Aviagen info@aviagen.com www.aviagen.com
Aviagen Turkeys Ltd turkeysltd@aviagen.com www.aviagenturkeys.com
Aza International info@azainternational.it www.azainternational.it
Babolna TETRA info@babolnatetra.com www.babolnatetra.com
Barbieri Belts info@barbieri-belts.com www.barbieribelts.com
BD Agricoltura Italia S.r.l. italia@bigdutchman.com www.bigdutchman.it
Biochem ber tarelli@biochem.net www.biochem.net
Biolab 2000 biolabvr@tiscalinet.it www.biolab2000.it
Carfed International Ltd carfed@carfed.co.uk
Carfed International Ltd Italy carfed@carfed.it www.carfed.it
Chick Farm Europe info@chickeurope.com www.novogen-layers.com
Cizo info@cizo.it www.cizo.it
Clerici Gino S.r.l. info@clerici.it www.clerici.it
Cobb Europe info@cobb-europe.com www.cobb-vantress.com
Codaf info@codaf.net www.codaf.net
Corti Zootecnici S.r.l. info@cortizootecnici.com www.cortizootecnici.it
DSM Nutritional Products info@dsm.com www.dsm.com
Elanco italia_elanco@elanco.com www.elanco.com
EuroTier eurotier@dlg.org www.eurotier.com
Evonik luca.iacoianni@evonik.com www.evonik.com
Facco Poultry Equipment facco@facco.net www.facco.net
FIEM fiem@fiem.it www.fiem.it
FierAgricola Verona fieragricola@veronafiere.it www.fieragricola.it
FierAvicola info@fieravicola.com www.fieravicola.com
Gasolec sales@gasolec.com www.gasolec.com
GI-OVO B.V. sales@gi-ovo.com www.gi-ovo.com
Giordano Poultry Plast info@poultryplast.com www.poultryplast.com
Hendrix Genetics info@hendrix-genetics.com www.hendrix-genetics.com
Hubbard contact.emea@hubbardbreeders.com www.hubbardbreeders.com
Hy-Line International info@hyline.com www.hyline.com
Impex Barneveld BV info@impex.nl www.impex.nl
Intracare info@intracareitaly.com www.intracare.nl
Lallemand animalitaly@lallemand.com www.lallemandanimalnutrition.com
Lubing System info@lubing.it www.lubingsystem.com
Marel info.poultry@marel.com www.marel.com/en/poultry
Mbe Breeding Equipment info@mbefabriano www.mbefabriano.it
Meyn sales@meyn.com www.meyn.com
MSD Animal Health S.r.l. www.msd-animal-health.it
Newpharm info@newpharm.it www.newpharm.it
Officine Meccaniche Vettorello luciano@officinevettorello.it www.officinevettorello.com
Petersime N.V. info@petersime.com www.petersime.com
Riva Selegg info@rivaselegg.com www.rivaselegg.com
Royal Pas Reform info@pasreform.com www.pasreform.com
Roxell info@roxell.com www.roxell.com
Reventa info.reventa@munters.de www.reventa.de
Sacco S.r.l. info@saccosystem.com www.saccosystem.com
Schropper office@schropper.at www.schropper.at
Ska ska@ska.it www.ska.it
Sime-Tek info@sime-tek.com www.sime-tek.com
Space info@space.fr www.space.fr
Specht Ten Elsen GmbH & Co. KG info@specht-tenelsen.de www.specht-tenelsen.de
Sperotto info@sperotto-spa.com www.sperotto-spa.com
Tezza tezza@tezza.it www.tezza.it
TPI-Polytechniek info@tpi-polytechniek.com www.tpi-polytechniek.com
Valli info@valli-italy.com www.valli-italy.com
Val-co intl.sales@val-co.com www.val-co.com
VDL Agrotech info@vdlagrotech.nl www.vdlagrotech.com
VDL Jansen info@vdljansen.com www.vdljansen.com
Vencomatic Group B.V. info@vencomaticgroup.com www.vencomaticgroup.com
Vétoquinol Italia italy_ascor@vetoquinol.com ascor.vetoquinol.it
Victoria victoria@victoria-srl.com www.incubatricivictoria.com
Direttore responsabile
Lucio Vernillo
Redazione
Daria Domenici (zootecnica@zootecnica.it)
Referente Italia
Marianna Caterino (marianna@zootecnica.it)
Amministrazione amministrazione@zootecnica.it
Ufficio
Zootecnica International
Vicolo Libri, 4
50063 Figline Incisa Valdarno (FI) Italia
Tel.: +39 055 2571891
Web: zootecnica.it
Registrazione
Registrazione Tribunale di Firenze n.3162 Spedizione in A.P. Art.2 comma 20/B legge 662/96 - Filiale di Firenze
ISSN 0392-0593
Abbonamento (1 anno / 11 numeri): Italia Euro 50
Abbonamento
con Carta di credito o Paypal: zootecnica.it/abbonamenti
Abbonamento con bonifico bancario: Zootecnica International, Vicolo Libri, 4
50063 Figline Incisa Valdarno (FI) Italia; banca: UNICREDIT, BIC: UNICRITM1OU9
Iban: IT 81 H 02008 38083 000020067507
Art Direction e impaginazione
Laura Cardilicchia – elleciwebstudio.com
Copertina
© Denise Vernillo
Stampa
Nova Arti Grafiche, Firenze
Edizione italiana Anno XXXIV • Gennaio 2024




Giordano Poultry Plast progetta, sviluppa e produce da oltre 60 anni prodotti e soluzioni innovative per l'allevamento del pollame e il trasporto delle uova.

Tutti i prodotti sono adatti a diverse specie di animali volatili e per ogni fase di vita. La gamma di prodotti comprende coop e box per il trasporto, abbeveratoi manuali e non, mangiatoie in linea o individuali e posatoi studiati e progettati per mantenere un'elevata qualità dell'igiene nell'allevamento. Senza dimenticare il range completo per la movimentazione delle uova che comprende tray pensati per uova di diverse dimensioni fino a sistemi più complessi e automatizzati.

30


www.poultryplast.com
trovate dal
Ci
Gen - 1 Feb 2024
Stand B13043
allo



Symphiome™ Microbioma gestito con precisione












Quando si parla di salute intestinale ottimale, il microbioma dovrebbe funzionare come un’orchestra che suona in perfetta armonia. A dirigere questa orchestra è il Symphiome™, un Biotico di Precisione, unico nel suo genere. La modalità d’azione unica di Symphiome™ aumenta le funzioni metaboliche intrinseche del microbioma che detossificano gli amminoacidi non assorbiti e le proteine in eccesso, indipendentemente dalla composizione del microbiota.





Symphiome™ è il primo biotico di precisione nel suo genere che ottimizza la resilienza degli animali allo stress enterico, aiuta nell’utilizzo dei nutrienti, migliora il benessere, riduce le emissioni e supporta le performance anche durante situazioni stressanti.
Symphiome™. Microbioma gestito con precisione Se non noi, chi? Se non ora quando?





RENDIAMO POSSIBILE RIDUCE LE EMISSIONI OTTIMIZZA LA RESILIENZA A STRESS ENTERICO MIGLIORA IL BENESSERE DELL’ANIMALE MIGLIORA L’UTILIZZO DEI NUTRIENTI FEED | Follow us on: www.dsm.com/anh MANTIENE LE PERFORMANCE IN FASI STRESSANTI
LO